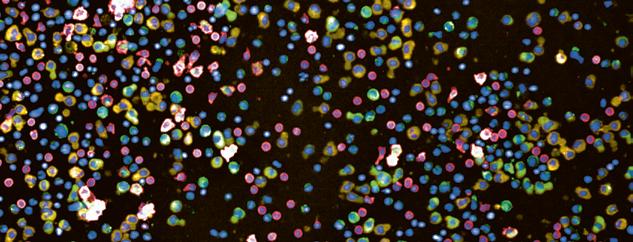

Publications
2022
Koch, Christian A; Fischer, Nina Charlotte; Puchert, Malte; Engele, Jürgen (2022). Interactions of the chemokines CXCL11 and CXCL12 in human tumor cells. BMC Cancer, 22:1335.
Akhoundova, Dilara; Hussung, Saskia; Sivakumar, Smruthy; Töpfer, Antonia; Rechsteiner, Markus; Kahraman, Abdullah; Arnold, Fabian; Angst, Florian; Britschgi, Christian; Zoche, Martin; Moch, Holger; Weber, Achim; Sokol, Ethan; Fritsch, Ralph M (2022). ROS1 genomic rearrangements are rare actionable drivers in microsatellite stable colorectal cancer. International Journal of Cancer, 151(12):2161-2171.
Ravandi, Farhad; Kreitman, Robert J; Tiacci, Enrico; et al; Zenz, Thorsten (2022). Consensus opinion from an international group of experts on measurable residual disease in hairy cell leukemia. Blood Cancer Journal, 12(12):165.
Haberecker, Martina; Bühler, Marco Matteo; Mendieta, Alicia Pliego; Guggenberger, Roman; Arnold, Fabian; Markert, Eva; Rechsteiner, Markus; Zoche, Martin; Britschgi, Christian; Pauli, Chantal (2022). Molecular and immunophenotypic characterization of SMARCB1 (INI1) - deficient intrathoracic Neoplasms. Modern Pathology, 35(12):1860-1869.
Deuel, Jeremy Werner; Lauria, Elisa; Lovey, Thibault; Zweifel, Sandrine; Meier, Mara Isabella; Züst, Roland; Gültekin, Nejla; Stettbacher, Andreas; Schlagenhauf, Patricia (2022). Persistence, prevalence, and polymorphism of sequelae after COVID-19 in unvaccinated, young adults of the Swiss Armed Forces: a longitudinal, cohort study (LoCoMo). Lancet Infectious Diseases, 22(12):1694-1702.
Cantoni, Nathan; Sommavilla, Roberto; Seitz, Patrick; Kulenkampff, Elisabeth; Kahn, Stefan; Lambert, Jean-François; Schmidt, Adrian; Zenhaeusern, Reinhard; Balabanov, Stefan (2022). A multicenter real-world evidence study in the Swiss treatment landscape of chronic myeloid leukemia. BMC Cancer, 22:1192.
Abrisqueta, Pau; Medina-Gil, Daniel; Villacampa, Guillermo; Lu, Junyan; Alcoceba, Miguel; Carabia, Julia; Boix, Joan; Tazón-Vega, Barbara; Iacoboni, Gloria; Bobillo, Sabela; Marín-Niebla, Ana; González, Marcos; Zenz, Thorsten; Crespo, Marta; Bosch, Francesc (2022). A gene expression assay based on chronic lymphocytic leukemia activation in the microenvironment to predict progression. Blood Advances, 6(21):5763-5773.
Ruder, Josefine; Docampo, María José; Rex, Jordan; Obahor, Simon; Naghavian, Reza; Müller, Antonia M S; Schanz, Urs; Jelcic, Ilijas; Martin, Roland (2022). Dynamics of T cell repertoire renewal following autologous hematopoietic stem cell transplantation in multiple sclerosis. Science Translational Medicine, 14(669):eabq1693.
von Niederhäusern, Valentin; Ruder, Josefine; Ghraichy, Marie; Jelcic, Ilijas; Müller, Antonia Maria; Schanz, Urs; Martin, Roland; Trück, Johannes (2022). B-Cell Reconstitution After Autologous Hematopoietic Stem Cell Transplantation in Multiple Sclerosis. Neurology: Neuroimmunology and Neuroinflammation, 9(6):e200027.
Schürch, Patrick M; Malinovska, Liliana; Hleihil, Mohammad; Losa, Marco; Hofstetter, Mara C; Wildschut, Mattheus H E; Lysenko, Veronika; Lakkaraju, Asvin K K; Maat, Christina A; Benke, Dietmar; Aguzzi, Adriano; Wollscheid, Bernd; Picotti, Paola; Theocharides, Alexandre P A (2022). Calreticulin mutations affect its chaperone function and perturb the glycoproteome. Cell Reports, 41(8):111689.
Fischer, Alessa; Bankel, Lorenz; Hiltbrunner, Stefanie; Rechsteiner, Markus; Rüschoff, Jan H; Rushing, Elisabeth Jane; Britschgi, Christian; Curioni-Fontecedro, Alessandra (2022). Mutational Landscape and Expression of PD-L1 in Patients with Non-Small Cell Lung Cancer Harboring Genomic Alterations of the MET gene. Targeted oncology, 17(6):683-694.
Papachristofilou, Alexandros; Bedke, Jens; Hayoz, Stefanie; Schratzenstaller, Ulrich; Pless, Miklos; Hentrich, Marcus; Krege, Susanne; Lorch, Anja; Aebersold, Daniel-M; Putora, Paul Martin; Berthold, Dominik-R; Zihler, Deborah; Zengerling, Friedemann; Dieing, Annette; Mueller, Arndt-Christian; Schaer, Corinne; Biaggi, Christine; Gillessen, Silke; Cathomas, Richard (2022). Single-dose carboplatin followed by involved-node radiotherapy for stage IIA and stage IIB seminoma (SAKK 01/10): a single-arm, multicentre, phase 2 trial. Lancet Oncology, 23(11):1441-1450.
Fiskus, Warren; Daver, Naval; Boettcher, Steffen; Mill, Christopher P; Sasaki, Koji; Birdwell, Christine E; Davis, John A; Das, Kaberi; Takahashi, Koichi; Kadia, Tapan M; DiNardo, Courtney D; Burrows, Francis; Loghavi, Sanam; Khoury, Joseph D; Ebert, Benjamin L; Bhalla, Kapil N (2022). Activity of menin inhibitor ziftomenib (KO539) as monotherapy or in combinations against AML cells with MLL1 rearrangement or mutant NPM1. Leukemia, 36(11):2729-2733.
Weller, Marie-Christine; Haralambieva, Eugenia; Bühler, Marco Matteo; Benz, Rudolf; Theocharides, Alexandre Pierre André; Balabanov, Stefan (2022). CALR loss-of-heterozygosity as a potential driver for extramedullary AML. Annals of Hematology, 101(11):2571-2573.
Bührer, Elias D; Amrein, Michael A; Förster, Stefan; Isringhausen, Stephan; Schürch, Christian M; Bhate, Salil S; Brodie, Tess; Zindel, Joel; Stroka, Deborah; Sayed, Mohamad Al; Nombela-Arrieta, César; Radpour, Ramin; Riether, Carsten; Ochsenbein, Adrian F (2022). Splenic red pulp macrophages provide a niche for CML stem cells and induce therapy resistance. Leukemia, 36(11):26342646.
Herbst, Sophie A; Vesterlund, Mattias; Helmboldt, Alexander J; et al; Zenz, Thorsten (2022). Proteogenomics refines the molecular classification of chronic lymphocytic leukemia. Nature Communications, 13(1):6226.
Mangolini, Maurizio; Maiques-Diaz, Alba; Charalampopoulou, Stella; Gerhard-Hartmann, Elena; Bloehdorn, Johannes; Moore, Andrew; Giachetti, Giorgia; Lu, Junyan; Roamio Franklin, Valar Nila; Chilamakuri, Chandra Sekkar Reddy; Moutsopoulos, Ilias; Rosenwald, Andreas; Stilgenbauer, Stephan; Zenz, Thorsten; Mohorianu, Irina; D’Santos, Clive; Deaglio, Silvia; Hodson, Daniel J; Martin-Subero, Jose I; Ringshausen, Ingo (2022). Viral transduction of primary human lymphoma B cells reveals mechanisms of NOTCH-mediated immune escape. Nature Communications, 13:6220.
13
58
Caiado, Francisco; Manz, Markus G (2022). TLR1/2-stimulated DCs “prime” HSCs via IL-1 β. Blood, 140(14):1576-1578.
Kleber, Martina; Wicki, Andreas; Cheetham, Marcus (2022). Strategien zur gemeinsamen Entscheidungsfindung in der Therapie bei Patient_innen mit onkologischen Erkrankungen - Quo vadis? Therapeutische Umschau. Revue thérapeutique, 79(8):401-408.
Felip, Enriqueta; Smit, Egbert F; Molina-Vila, Miguel A; Dafni, Urania; et al; Britschgi, Christian; Kammler, Roswitha; Ruepp, Barbara; Roschitzki-Voser, Heidi; Peters, Solange (2022). Alectinib for the treatment of pretreated RET-rearranged advanced NSCLC: Results of the ETOP ALERT-lung trial. Lung Cancer, 172:94-99.
Zeeb, Marius; Weissberg, Dana; Rampini, Silvana K; Müller, Rouven; Scheier, Thomas; Zingg, Walter; Kouyos, Roger D; Wolfensberger, Aline (2022). Identifying Contact Risks for SARS-CoV-2 Transmission to Healthcare Workers during Outbreak on COVID-19 Ward. Emerging Infectious Diseases, 28(10):2134-2137.
Gerger, Armin; Eisterer, Wolfgang; Fuxius, Stefan; Bastian, Sara; et al; Sanoyan, Dilara Akhoundova; Fritsch, Ralph (2022). Retrospective Analysis of Treatment Pathways in Patients With BRAFV600E-mutant Metastatic Colorectal Carcinoma – MORSECRC. Anticancer Research, 42(10):4773-4785.
Farmakis, Loannis T; Barco, Stefano; Hobohm, Lukas; Braekkan, Sigrid K; Connors, Jean M; Giannakoulas, George; Hunt, Beverley J; Keller, Karsten; Mavromanoli, Anna C; Trinchero, Alice; Konstantinides, Stavros V; Valerio, Luca (2022). Maternal mortality related to pulmonary embolism in the United States, 2003-2020. American Journal of Obstetrics and Gynecology MFM, 5(1):100754.
Sparano, Colin; Solís-Sayago, Darío; Vijaykumar, Anjali; Rickenbach, Chiara; Vermeer, Marijne; Ingelfinger, Florian; Litscher, Gioana; Fonseca, André; Mussak, Caroline; Mayoux, Maud; Friedrich, Christin; Nombela-Arrieta, César; Gasteiger, Georg; Becher, Burkhard; Tugues, Sonia (2022). Embryonic and neonatal waves generate distinct populations of hepatic ILC1s. Science Immunology, 7(75):eabo6641.
Adamina, Michel; Warlaumont, Maxime; Berger, Martin D; Däster, Silvio; Delaloye, Raphaël; Digklia, Antonia; Gloor, Beat; Fritsch, Ralph; Koeberle, Dieter; Koessler, Thibaud; Lehmann, Kuno; Müller, Phaedra; Peterli, Ralph; Ris, Frédéric; Steffen, Thomas; Weisshaupt, Christian Stefan; Hübner, Martin (2022). Comprehensive Treatment Algorithms of the Swiss Peritoneal Cancer Group for Peritoneal Cancer of Gastrointestinal Origin. Cancers, 14(17):4275.
Speich, Benjamin; Chammartin, Frédérique; Abela, Irene A; Amico, Patrizia; Stoeckle, Marcel P; Eichenberger, Anna L; Hasse, Barbara; Braun, Dominique L; Schuurmans, Macé M; Müller, Thomas F; Tamm, Michael; Audigé, Annette; Mueller, Nicolas J; Rauch, Andri; Günthard, Huldrych F; Koller, Michael T; Trkola, Alexandra; Briel, Matthias; Kusejko, Katharina; Bucher, Heiner C; et al; Schanz, Urs (2022). Antibody Response in Immunocompromised Patients After the Administration of Severe Acute Respiratory Syndrome Coronavirus 2 (SARS-CoV-2) Vaccine BNT162b2 or mRNA-1273: A Randomized Controlled Trial. Clinical Infectious Diseases, 75(1):e585-e593.
Sellar, Rob S; Sperling, Adam S; Słabicki, Mikołaj; Gasser, Jessica A; et al; Boettcher, Steffen (2022). Degradation of GSPT1 causes TP53-independent cell death in leukemia while sparing normal hematopoietic stem cells. Journal of Clinical Investigation, 132(16):e153514.
Andermatt, Rea; Bloemberg, Guido V; Ganter, Christoph C; Mueller, Nicolas J; Mueller, Antonia M S; Muellhaupt, Beat; Kielstein, Jan T; David, Sascha (2022). Elimination of Herpes Simplex Virus-2 and Epstein-Barr Virus With Seraph 100 Microbind Affinity Blood Filter and Therapeutic Plasma Exchange: An Explorative Study in a Patient With Acute Liver Failure. Critical Care Explorations, 4(8):e0745.
Wilk, C Matthias; Kovtonyuk, Larisa V; Manz, Markus G (2022). Addition of romiplostim to conditioning prior to HSCT allows chemotherapy reduction while maintaining engraftment levels. Blood Advances, 6(15):4485-4489.
Wagner, Ulrich; Wong, Christine; Camenisch, Ulrike; Zimmermann, Kathrin; Rechsteiner, Markus; Valtcheva, Nadejda; Theocharides, Alexandre; Widmer, Corinne C; Manz, Markus G; Moch, Holger; Wild, Peter J; Balabanov, Stefan (2022). Comprehensive Validation of Diagnostic Next-Generation Sequencing Panels for Acute Myeloid Leukemia Patients. Journal of Molecular Diagnostics, 24(8):935954.
Adenaeuer, Anke; Barco, Stefano; Trinchero, Alice; Lackner, Karl J; Lämmle, Bernhard; Rossmann, Heidi (2022). Definite diagnosis of plasma prekallikrein deficiency should not be based exclusively on shortening of the aPTT upon prolonged pre-incubation. International Journal of Laboratory Hematology, 44(4):e179-e180.
Bruch, Peter-Martin; Giles, Holly Ar; Kolb, Carolin; Herbst, Sophie A; Becirovic, Tina; Roider, Tobias; Lu, Junyan; Scheinost, Sebastian; Wagner, Lena; Huellein, Jennifer; Berest, Ivan; Kriegsmann, Mark; Kriegsmann, Katharina; Zgorzelski, Christiane; Dreger, Peter; Zaugg, Judith B; Müller-Tidow, Carsten; Zenz, Thorsten; Huber, Wolfgang; Dietrich, Sascha (2022). Drug-microenvironment perturbations reveal resistance mechanisms and prognostic subgroups in CLL. Molecular Systems Biology, 18(8):e10855.
Falanga, Anna; Leader, Avi; Ambaglio, Chiara; Bagoly, Zsuzsa; Castaman, Giancarlo; Elalamy, Ismail; Lecumberri, Ramon; Niessner, Alexander; Pabinger, Ingrid; Szmit, Sebastian; Trinchero, Alice; Ten Cate, Hugo; Rocca, Bianca (2022). EHA Guidelines on Management of Antithrombotic Treatments in Thrombocytopenic Patients With Cancer. HemaSphere, 6(8):e750.
Rösler, Wiebke; Zenz, Thorsten (2022). GOALs in relapsed DLBCL. British Journal of Haematology, 198(3):419-420.
Batzilla, Alina; Lu, Junyan; Kivioja, Jarno; Putzker, Kerstin; Lewis, Joe; Zenz, Thorsten; Huber, Wolfgang (2022). Inferring tumor-specific cancer dependencies through integrating ex vivo drug response assays and drug-protein profiling. PLoS Computational Biology, 18(8):e1010438.
Kahraman, Abdullah; Arnold, Fabian M; Hanimann, Jacob; Nowak, Marta; Pauli, Chantal; Britschgi, Christian; Moch, Holger; Zoche, Martin (2022). MTPpilot: An Interactive Software for Visualization of Next-Generation Sequencing Results in Molecular Tumor Boards. JCO Clinical Cancer Informatics, 6:e2200032.
Ring, Alexander; Grob, Björn; Aerts, Erik; Ritter, Katharina; Volbracht, Jörk; Schär, Bettina; Greiling, Michael; Müller, Antonia M S (2022). Resource utilization for chimeric antigen receptor T cell therapy versus autologous hematopoietic cell transplantation in patients with B cell lymphoma. Annals of Hematology, 101(8):1755-1767.
Krebs, Fanny S; Britschgi, Christian; Pradervand, Sylvain; Achermann, Rita; Tsantoulis, Petros; Haefliger, Simon; Wicki, Andreas; Michielin, Olivier; Zoete, Vincent (2022). Structure-based prediction of BRAF mutation classes using machine-learning approaches. Scientific Reports, 12(1):12528.
Sathanantham, Vepusha; Alberio, Lorenzo; Bovet, Cédric; Fontana, Pierre; Gerber, Bernhard; Graf, Lukas; Mendez, Adriana; Sauter, Thomas C; Schmidt, Adrian; Studt, Jan-Dirk; Wuillemin, Walter A; Nagler, Michael (2022). Prothrombinase-Induced Clotting Time to Measure Drug Concentrations of Rivaroxaban, Apixaban, and Edoxaban in Clinical Practice: A Cross-Sectional Study. Life, 12(7):1027.
59
Taromi, Sanaz; Firat, Elke; Simonis, Alexander; Braun, Lukas M; Apostolova, Petya; Elze, Mirjam; Passlick, Bernward; Schumacher, Alicia; Lagies, Simon; Frey, Anna; Schmitt-Graeff, Annette; Burger, Meike; Schmittlutz, Katrin; Follo, Marie; von Elverfeldt, Dominik; Zhu, Xuekai; Kammerer, Bernd; Diederichs, Sven; Duyster, Justus; Manz, Markus G; Niedermann, Gabriele; Zeiser, Robert (2022). Enhanced AC133-specific CAR T cell therapy induces durable remissions in mice with metastatic small cell lung cancer. Cancer Letters, 538:215697.
Limani, Perparim; Garcia Schüler, Helena; Fritsch, Ralph M; Turina, Matthias (2022). Multimodale Therapiekonzepte beim Rektumkarzinom. Schweizer Gastroenterologie, 3(2):65-74.
Taromi, Sanaz; Firat, Elke; Simonis, Alexander; et al; Manz, Markus G (2022). Retraction notice to “Enhanced AC133-specific CAR T cell therapy induces durable remissions in mice with metastatic small cell lung cancer” [Canc. Lett. 520 (2021) 385-399]. Cancer Letters, 537:215680.
Rösler, Wiebke; Bink, Andrea; Bissig, Marina; Imbach, Lukas; Marques Maggio, Ewerton; Manz, Markus G; Müller, Thomas; Roth, Patrick; Rushing, Elisabeth; Widmer, Corinne; Zenz, Thorsten; von Moos, Seraina; Müller, Antonia M S (2022). CAR T-cell Infusion Following Checkpoint Inhibition Can Induce Remission in Chemorefractory Post-transplant Lymphoproliferative Disorder of the CNS. HemaSphere, 6(7):e733.
White, Helen E; Salmon, Matthew; Albano, Francesco; et al; Balabanov, Stefan (2022). Standardization of molecular monitoring of CML: results and recommendations from the European treatment and outcome study. Leukemia, 36(7):1834-1842.
Stolz, Sebastian; Roncador, Marco; Rösler, Wiebke; Zenz, Thorsten; Manz, Markus G; Müller, Antonia M S; Widmer, Corinne C (2022). Introducing innovative cellular therapies into the clinic: a 2-year retrospective experience of a chimeric antigen receptor T-cell programme at a single centre in Switzerland. Swiss Medical Weekly, 152:w30186.
Mughal, Farah Perveen; Bergmann, Ann Christina; Huynh, Ha Uyen Buu; Jørgensen, Sarah Hyllekvist; Mansha, Inaam; Kesmez, Meliha; Schürch, Patrick Mark; Theocharides, Alexandre Pierre André; Hansen, Paul Robert; Friis, Tina; Holmström, Morten Orebo; Ciplys, Evaldas; Slibinskas, Rimantas; Højrup, Peter; Houen, Gunnar; Trier, Nicole Hartwig (2022). Production and Characterization of Peptide Antibodies to the C-Terminal of Frameshifted Calreticulin Associated with Myeloproliferative Diseases. International Journal of Molecular Sciences, 23(12):6803.
Marconato, Maddalena; Abela, Irene A; Hauser, Anthony; Schwarzmüller, Magdalena; Katzensteiner, Rheliana; Braun, Dominique L; Epp, Selina; Audigé, Annette; Weber, Jacqueline; Rusert, Peter; Schindler, Eméry; Pasin, Chloé; West, Emily; Böni, Jürg; Kufner, Verena; Huber, Michael; Zaheri, Maryam; Schmutz, Stefan; Frey, Beat M; Kouyos, Roger D; Günthard, Huldrych F; Manz, Markus G; Trkola, Alexandra (2022). Antibodies from convalescent plasma promote SARS-CoV-2 clearance in individuals with and without endogenous antibody response. Journal of Clinical Investigation, 132(12):e158190.
Tan, Ge; Wolski, Witold Eryk; Kummer, Sandra; Hofstetter, Mara Carina; Theocharides, Alexandre P A; Manz, Markus G; Aebersold, Ruedi; Meier-Abt, Fabienne (2022). Proteomic identification of proliferation and progression markers in human polycythemia vera stem and progenitor cells. Blood Advances, 6(11):3480-3493.
Schimmer, Roman R; Kovtonyuk, Larisa Vladimirovna; Klemm, Nancy; Fullin, Jonas; Stolz, Sebastian M; Mueller, Jan; Caiado, Francisco; Kurppa, Kari J; Ebert, Benjamin L; Manz, Markus G; Boettcher, Steffen (2022). TP53 mutations confer resistance to hypo-
methylating agents and BCL-2 inhibition in myeloid neoplasms. Blood Advances, 6(11):3201-3206.
Mende, Nicole; Bastos, Hugo P; Santoro, Antonella; Mahbubani, Krishnaa T; Ciaurro, Valerio; Calderbank, Emily Francesca; Quiroga Londoño, Mariana; Sham, Kendig; Mantica, Giovanna; Morishima, Tatsuya; Mitchell, Emily; Lidonnici, Maria Rosa; Meier-Abt, Fabienne; Hayler, Daniel; Jardine, Laura; Curd, Abbie; Haniffa, Muzlifah; Ferrari, Giuliana; Takizawa, Hitoshi; Wilson, Nicola K; Gottgens, Bertie; Saeb-Parsy, Kourosh; Frontini, Mattia; Laurenti, Elisa (2022). Unique molecular and functional features of extramedullary hematopoietic stem and progenitor cell reservoirs in humans. Blood, 139(23):3387-3401.
Liberini, Virginia; Pizzuto, Daniele A; Messerli, Michael; Orita, Erika; Grünig, Hannes; Maurer, Alexander; Mader, Cäcilia; Husmann, Lars; Deandreis, Désirée; Kotasidis, Fotis; Trinckauf, Josey; Curioni, Alessandra; Opitz, Isabelle; Winklhofer, Sebastian; Huellner, Martin W (2022). BSREM for Brain Metastasis Detection with 18F-FDGPET/CT in Lung Cancer Patients. Journal of Digital Imaging, 35(3):581-593.
Benoit, Tobias M; Rieger, Max J; Stolz, Sebastian M (2022). A curious case of a neutrophilic horn. The Lancet Haematology, 9(6):e460.
Veillon, Rémi; Sakai, Hiroshi; Le, Xiuning; Felip, Enriqueta; et al; Britschgi, Christian (2022). Safety of Tepotinib in Patients With MET Exon 14 Skipping NSCLC and Recommendations for Management. Clinical Lung Cancer, 23(4):320-332.
Radke, Josefine; Ishaque, Naveed; Koll, Randi; et al; Zenz, Thorsten (2022). The genomic and transcriptional landscape of primary central nervous system lymphoma. Nature Communications, 13:2558.
Fankhauser, Christian D; Christiansen, Ailsa J; Rothermundt, Christian; Cathomas, Richard; Wettstein, Marian S; Grossmann, Nico C; Grogg, Josias B; Templeton, Arnoud J; Hirschi-Blickenstorfer, Anita; Lorch, Anja; Gillessen, Silke; Moch, Holger; Beyer, Joerg; Hermanns, Thomas (2022). Detection of recurrences using serum miR-371a-3p during active surveillance in men with stage I testicular germ cell tumours. British Journal of Cancer, 126(8):1140-1144.
Ring, Alexander; Lang, Julie E (2022). ASO Author Reflections: Advancing Circulating Tumor Cells as Liquid Biopsies to Efficiently Target Metastatic Breast Cancer. Annals of Surgical Oncology, 29(5):2895-2896.
Ring, Alexander; Campo, Daniel; Porras, Tania B; Kaur, Pushpinder; Forte, Victoria A; Tripathy, Debu; Lu, Janice; Kang, Irene; Press, Michael F; Jeong, Young Ju; Snow, Anson; Zhu, Yue; Zada, Gabriel; Wagle, Naveed; Lang, Julie E (2022). Circulating Tumor Cell Transcriptomics as Biopsy Surrogates in Metastatic Breast Cancer. Annals of Surgical Oncology, 29(5):2882-2894.
Ring, Alexander; Campo, Daniel; Porras, Tania B; Kaur, Pushpinder; Forte, Victoria A; Tripathy, Debu; Lu, Janice; Kang, Irene; Press, Michael F; Jeong, Young Ju; Snow, Anson; Zhu, Yue; Zada, Gabriel; Wagle, Naveed; Lang, Julie E (2022). Correction to: Circulating Tumor Cell Transcriptomics as Biopsy Surrogates in Metastatic Breast Cancer. Annals of Surgical Oncology, 29(5):3064.
Hofer, Kevin D; Schanz, Urs; Schwotzer, Rahel; Nair, Gayathri; Manz, Markus G; Widmer, Corinne C (2022). Real-world outcomes in elderly ALL patients with and without allogeneic hematopoietic stem cell transplantation: a single-center evaluation over 10 years. Annals of Hematology, 101(5):1097-1106.
Li, Weiye; Liu, Yu-Hang; Estrada, Héctor; Rebling, Johannes; Reiss, Michael; Galli, Serena; Nombela-Arrieta, Cesar; Razansky, Daniel (2022). Tracking Strain-Specific Morphogenesis and Angiogenesis of Murine Calvaria with Large-Scale Optoacoustic and Ultrasound Microscopy. Journal of Bone and Mineral Research, 37(5):1032-1043.
60
Joerger, Markus; Metaxas, Yannis; Zaman, Khalil; Michielin, Olivier; Mach, Nicolas; Bettini, Adrienne; Schmitt, Andreas M; Cantoni, Nathan; Caspar, Clemens B; Stettler, Sonja; Malval, Roma; Pless, Miklos; Britschgi, Christian; Renner, Christoph; Koeberle, Dieter; Schulz, Jessica D; Kopp, Christoph; Hayoz, Stefanie; Stathis, Anastasios; von Moos, Roger; Swiss Group for Clinical Cancer Research (SAKK) (2022). Outcome and Prognostic Factors of COVID-19 Infection in Swiss Cancer Patients: Final Results of SAKK 80/20 (CaSA). Cancers, 14(9):2191.
Linnik, Janina; Syedbasha, Mohammedyaseen; Kaltenbach, Hans-Michael; Vogt, Dominik; Hollenstein, Yvonne; Kaufmann, Lukas; Cantoni, Nathan; Ruosch-Girsberger, Sabine; Müller, Antonia M S; Schanz, Urs; Müller Pabst, Thomas; Stüssi, Georg; Weisser, Maja; Halter, Jörg; Stelling, Jörg; Egli, Adrian (2022). Association of host factors with antibody response to seasonal influenza vaccination in allogeneic hematopoietic stem cell transplant (HSCT) patients. Journal of Infectious Diseases, 225(8):1482-1493.
Scherer, Clemens; Lüsebrink, Enzo; Kupka, Danny; Stocker, Thomas J; Stark, Konstantin; Kleeberger, Jan; Orban, Mathias; Kellnar, Antonia; Petzold, Tobias; Deseive, Simon; Krieg, Kathrin; Würbel, Sara; Kika, Sara; Istrefi, Mario; Brunner, Stefan; Braun, Daniel; Hagl, Christian; Hausleiter, Jörg; Massberg, Steffen; Sibbing, Dirk; Orban, Martin (2022). ADP-induced platelet reactivity and bleeding events in patients with acute myocardial infarction complicated by cardiogenic shock. Platelets, 33(3):371-380.
Bauml, Joshua M; Li, Bob T; Velcheti, Vamsidhar; Govindan, Ramaswamy; Curioni-Fontecedro, Alessandra; Dooms, Christophe; Takahashi, Toshiaki; Duda, Andrew W; Odegaard, Justin I; Cruz-Guilloty, Fernando; Jin, Liming; Zhang, Ying; Anderson, Abraham; Skoulidis, Ferdinandos (2022). Clinical validation of Guardant360 CDx as a blood-based companion diagnostic for sotorasib. Lung Cancer, 166:270-278.
Zampiccoli, Emanuel; Barthelmes, Jens; Kreysing, Leonie; Nägele, Matthias P; Nebunu, Delia; Haider, Thomas; von Eckardstein, Arnold; Gerber, Bernhard; Schwotzer, Rahel; Ruschitzka, Frank; Sudano, Isabella; Flammer, Andreas J (2022). Eyes on amyloidosis: microvascular retinal dysfunction in cardiac amyloidosis. ESC Heart Failure, 9(2):1186-1194.
Bertram, Katrin; Leary, Peter John; Boudesco, Christophe; Fullin, Jonas; Stirm, Kristin; Dalal, Vineet; Zenz, Thorsten; Tzankov, Alexandar; Müller, Anne (2022). Inhibitors of Bcl-2 and Bruton’s tyrosine kinase synergize to abrogate diffuse large B-cell lymphoma growth in vitro and in orthotopic xenotransplantation models. Leukemia, 36(4):1035-1047.
Huang, Alice; Cicin-Sain, Caroline; Pasin, Chloé; Epp, Selina; Audigé, Annette; Müller, Nicolas J; Nilsson, Jakob; Bankova, Andriyana; Wolfensberger, Nathan; Vilinovszki, Oliver; Nair, Gayathri; Hockl, Philipp; Schanz, Urs; Kouyos, Roger D; Hasse, Barbara; Zinkernagel, Annelies S; Trkola, Alexandra; Manz, Markus G; Abela, Irene A; Müller, Antonia M S (2022). Antibody Response to SARS-CoV-2 Vaccination in Patients following Allogeneic Hematopoietic Cell Transplantation. Transplantation and Cellular Therapy, 28(4):214.e1-214. e11.
Bankova, Andriyana K; Caveney, Joseph; Yao, Bin; Ramos, Teresa L; Bögeholz, Jan; Heydari, Kartoosh; Diaz, Nery; Jackson, Marin L; Lowsky, Robert; Brown, Janice (Wes); Johnston, Laura; Rezvani, Andrew R; Frank, Matthew J; Muffly, Lori; Weng, Wen-Kai; Sidana, Surbhi; Negrin, Robert S; Miklos, David B; Shiraz, Parveen; Meyer, Everett H; Shizuru, Judith A; Arai, Sally (2022). Real-World Experience of Cryopreserved Allogeneic Hematopoietic Grafts during the COVID-19 Pandemic: A Single-Center Report. Transplantation and Cellular Therapy, 28(4):215.e1-215.e10.
Loeffler, Dirk; Schneiter, Florin; Wang, Weijia; Wehling, Arne; Kull, Tobias; Lengerke, Claudia; Manz, Markus G; Schroeder, Timm (2022). Asymmetric organelle inheritance predicts human blood stem cell fate. Blood, 139(13):2011-2023.
Le, Xiuning; Sakai, Hiroshi; Felip, Enriqueta; Veillon, Remi; Garassino, Marina Chiara; et al; Britschgi, Christian (2022). Tepotinib Efficacy and Safety in Patients with MET Exon 14 Skipping NSCLC: Outcomes in Patient Subgroups from the VISION Study with Relevance for Clinical Practice. Clinical Cancer Research, 28(6):11171126.
Meloni, Claudia; Schreiber, Cornelia; Studt, Jan-Dirk; Kamm, Simone; Di Chiara, Manuela; Herren, Thomas (2022). Liver infarctions as the first manifestation of antiphospholipid antibody syndrome in pregnancy: a case report. Journal of Medical Case Reports, 16:103.
Lickert, Sebastian; Kenny, Martin; Selcuk, Kateryna; Mehl, Johanna L; Bender, Markus; Früh, Susanna M; Burkhardt, Melanie A; Studt, Jan-Dirk; Nieswandt, Bernhard; Schoen, Ingmar; Vogel, Viola (2022). Platelets drive fibronectin fibrillogenesis using integrin α IIb β 3. Science Advances, 8(10):eabj8331.
Zapatka, Marc; Tausch, Eugen; Öztürk, Selcen; Yosifov, Deyan Yordanov; Seiffert, Martina; Zenz, Thorsten; Schneider, Christof; Blöhdorn, Johannes; Döhner, Hartmut; Mertens, Daniel; Lichter, Peter; Stilgenbauer, Stephan (2022). Clonal evolution in chronic lymphocytic leukemia is scant in relapsed but accelerated in refractory cases after chemo(immune)therapy. Haematologica, 107(3):604614.
Schlagenhauf, Patricia; Deuel, Jeremy (2022). Concerts and COVID: can the beat go on? Lancet Infectious Diseases, 22(3):299301.
Schulze, Jan Ben; Günther, Moritz Philipp; Riemenschnitter, Cosima; Wicki, Andreas; von Känel, Roland; Euler, Sebastian (2022). Distinct psycho-oncological support inclinations and needs in patients with cancer: A large sample latent class analysis approach. General Hospital Psychiatry, 75:17-22.
Schrader, Markus; Oberkofler, Christian Eugen; Pietge, Heike; Pavic, Matea; Petrowsky, Henrik; Guckenberger, Matthias; Garcia Schueler, Helena Isabel (2022). Stereotactic Irradiation of the Pancreas: Case Study of a Patient With Persistent Pancreatic Fistula. Pancreas, 51(3):e62-e63.
Malehmir, Mohsen; Pfister, Dominik; Gallage, Suchira; Szydlowska, Marta; Inverso, Donato; Kotsiliti, Elena; Leone, Valentina; Peiseler, Moritz; Surewaard, Bas G J; Rath, Dominik; Ali, Adnan; Wolf, Monika Julia; Drescher, Hannah; Healy, Marc E; Dauch, Daniel; Kroy, Daniela; Krenkel, Oliver; Kohlhepp, Marlene; Engleitner, Thomas; Olkus, Alexander; Sijmonsma, Tjeerd; Volz, Julia; Deppermann, Carsten; Stegner, David; Helbling, Patrick; Nombela-Arrieta, César; Rafiei, Anahita; Hinterleitner, Martina; Rall, Marcel; Baku, Florian; Weber, Achim; et al (2022). Author Correction: Platelet GPIb α is a mediator and potential interventional target for NASH and subsequent liver cancer. Nature Medicine, 28(3):600.
Brezina, T; von Dewitz, H; Schroeder, T; Ullrich, S; Nachtkamp, K; Reifenberger, G; Malzkorn, B; Sabel, M; Haas, R; Kobbe, G (2022). First-line high-dose therapy and autologous blood stem cell transplantation in patients with primary central nervous system non-Hodgkin lymphomas-a single-centre experience in 61 patients. Annals of Hematology, 101(3):607-616.
Tamò, Raphaël; Turk, Teja; Böni, Jürg; Kouyos, Roger D; Schmutz, Stefan; Huber, Michael; Shah, Cyril; Bischoff-Ferrari, Heike A; Distler, Oliver; Battegay, Edouard; Giovanoli, Pietro; Guckenberger, Matthias; Kohler, Malcolm; Müller, Rouven; Petry, Heidi; Ruschitzka, Frank; McGeer, Allison; Sax, Hugo; Weber, Rainer; Trkola, Alexandra; Kuster, Stefan P (2022). Secondary attack rates from asymptomatic and symptomatic influenza virus shedders in hospitals: Results from the TransFLUas influenza transmission study. Infection Control and Hospital Epidemiology, 43(3):312-318.
61
Van den Berg, Jana; Kremer Hovinga, Johanna A; Pfleger, Claudia; Hegemann, Inga; Stehle, Gregor Thomas; Holbro, Andreas; Studt, Jan-Dirk (2022). Daratumumab for immune thrombotic thrombocytopenic purpura. Blood Advances, 6(3):993-997.
Gomariz, Alvaro; Portenier, Tiziano; Nombela-Arrieta, César; Goksel, Orcun (2022). Probabilistic spatial analysis in quantitative microscopy with uncertainty-aware cell detection using deep Bayesian regression. Science Advances, 8(5):eabi8295.
Caiado, Francisco; Manz, Markus G (2022). A microbiome-macrophage-iron axis guides stressed hematopoietic stem cell fate. Cell Stem Cell, 29(2):177-179.
Bonfiglio, Ferdinando; Bruscaggin, Alessio; Guidetti, Francesca; Terzi di Bergamo, Lodovico; Faderl, Martin; Spina, Valeria; Condoluci, Adalgisa; Bonomini, Luisella; Forestieri, Gabriela; Koch, Ricardo; Piffaretti, Deborah; Pini, Katia; Pirosa, Maria Cristina; Cittone, Micol Giulia; Arribas, Alberto; Lucioni, Marco; Ghilardi, Guido; Wu, Wei; Arcaini, Luca; et al; Elia, Angela Rita; Calcinotto, Arianna; Ceriani, Luca; Cogliatti, Sergio; Gerber, Bernhard; Zenz, Thorsten; Moccia, Alden; Stathis, Anastasios (2022). Genetic and phenotypic attributes of splenic marginal zone lymphoma. Blood, 139(5):732747.
Krieg, Stefan; Seeger, Harald; Hofmann, Patrick; Del Prete, Carmen; Manz, Markus G; Müller, Antonia M; Theocharides, Alexandre P A (2022). Baseline creatinine predicts acute kidney injury during intensive therapy in transplant-eligible patients with acute myeloid leukaemia. British Journal of Haematology, 196(3):781-784.
Eshmuminov, Dilmurodjon; Hefti, Max; Mueller, Matteo; Schuler, Martin J; Bautista Borrego, Lucia; Schneider, Marcel André; Koch, Karin; Weisskopf, Miriam; Tibbitt, Mark W; Dutkowski, Philipp; Rudolf von Rohr, Philipp; Studt, Jan-Dirk; Becker, Dustin; Clavien, Pierre-Alain (2022). Synthesis of coagulation factors during long-term ex situ liver perfusion. Artificial Organs, 46(2):273-280.
Bakunina, Katerina; Putter, Hein; Versluis, Jurjen; Koster, Eva A S; van der Holt, Bronno; Manz, Markus G; Breems, Dimitri A; Gjertsen, Bjorn T; Cloos, Jacqueline; Valk, Peter J M; Passweg, Jakob; Pabst, Thomas; Ossenkoppele, Gert J; Löwenberg, Bob; Cornelissen, Jan J; de Wreede, Liesbeth C (2022). The added value of multi-state modelling in a randomized controlled trial: The HOVON 102 study re-analyzed. Cancer Medicine, 11(3):630-640.
Soo, R A; Han, J-Y; Dafni, U; Cho, B C; Yeo, C M; et al; Britschgi, Christian (2022). A randomised phase II study of osimertinib and bevacizumab versus osimertinib alone as second-line targeted treatment in advanced NSCLC with confirmed EGFR and acquired T790M mutations: the European Thoracic Oncology Platform (ETOP 10-16) BOOSTER trial. Annals of Oncology, 33(2):181-192.
Fehr, Thomas; Hübel, Kerstin; de Rougemont, Olivier; Abela, Irene; Gaspert, Ariana; Güngör, Tayfun; Hauri, Mathias; Helmchen, Birgit; Linsenmeier, Claudia; Müller, Thomas; Nilsson, Jakob; Riesterer, Oliver; Scandling, John D; Schanz, Urs; Cippà, Pietro E (2022). Successful Induction of Specific Immunological Tolerance by Combined Kidney and Hematopoietic Stem Cell Transplantation in HLA-Identical Siblings. Frontiers in Immunology, 13:796456.
Wilke, Anne C; Doebele, Carmen; Zindel, Alena; et al; Zenz, Thorsten (2022). SHMT2 inhibition disrupts the TCF3 transcriptional survival program in Burkitt lymphoma. Blood, 139(4):538-553.
Pavic, Matea; Niyazi, M; Wilke, Lotte; Corradini, Stefanie; Vornhülz, M; Mansmann, U; Al Tawil, A; Fritsch, Ralph; Hörner-Rieber, J; Debus, J; Guckenberger, Matthias; Belka, Claus; Mayerle, J; Beyer, G (2022). MR-guided adaptive stereotactic body radiotherapy (SBRT)
of primary tumor for pain control in metastatic pancreatic ductal adenocarcinoma (mPDAC): an open randomized, multicentric, parallel group clinical trial (MASPAC). Radiation Oncology, 17:18.
Fiskus, Warren; Boettcher, Steffen; Daver, Naval; Mill, Christopher P; Sasaki, Koji; Birdwell, Christine E; Davis, John A; Takahashi, Koichi; Kadia, Tapan M; DiNardo, Courtney D; Jin, Qi; Qi, Yuan; Su, Xiaoping; McGeehan, Gerard M; Khoury, Joseph D; Ebert, Benjamin L; Bhalla, Kapil N (2022). Effective Menin inhibitor-based combinations against AML with MLL rearrangement or NPM1 mutation (NPM1c). Blood Cancer Journal, 12(1):5.
Zarotti, Cristina; Papassotiropoulos, Bärbel; Elfgen, Constanze; Dedes, Konstantin; Vorburger, Denise; Pestalozzi, Bernhard; Trojan, Andreas; Varga, Zsuzsanna (2022). Biomarker dynamics and prognosis in breast cancer after neoadjuvant chemotherapy. Scientific Reports, 12:91.
Kovtonyuk, Larisa Vladimirovna; Caiado, Francisco; Garcia-Martin, Santiago; Manz, Eva-Maria; Helbling, Patrick Michael; Takizawa, Hitoshi; Boettcher, Steffen; Al-Shahrour, Fatima; Nombela-Arrieta, Cesar; Slack, Emma; Manz, Markus G (2022). IL-1 Mediates Microbiome-Induced Inflamm-Ageing of Hematopoietic Stem Cells in Mice. Blood, 139(1):44-58.
Voglis, Stefanos; Yildiz, Yesim; von Faber-Castell, Fabio; Harnisch, Kim Jannis; Regli, Luca; Bellut, David; Schwotzer, Rahel; Germans, Menno R (2022). Surgically treated intradural spinal manifestation of hereditary amyloidogenic transthyretin amyloidosis - A case report and scoping review of the literature. Brain and Spine, 2:100876.
Skawran, Stephan; Gennari, Antonio G; Dittli, Manuel; Treyer, Valerie; Muehlematter, Urs J; Maurer, Alexander; Burger, Irene A; Mader, Cäcilia; Messerli, Olivia; Grünig, Hannes; Gebhard, Catherine; Huellner, Martin W; Curioni-Fontecedro, Alessandra; Berger, Christoph; Messerli, Michael (2022). [ 18 F]FDG uptake of axillary lymph nodes after COVID-19 vaccination in oncological PET/CT: frequency, intensity, and potential clinical impact. European Radiology, 32(1):508-516.
Peters, S; Pujol, J-L; Dafni, U; Dómine, M; Popat, S; Reck, M; Andrade, J; Becker, A; Moro-Sibilot, D; Curioni-Fontecedro, A; Molinier, O; Nackaerts, K; Insa Mollá, A; Gervais, R; López Vivanco, G; Madelaine, J; Mazieres, J; Faehling, M; Griesinger, F; Majem, M; González Larriba, J L; Provencio Pulla, M; Vervita, K; Roschitzki-Voser, H; Ruepp, B; Mitchell, P; Stahel, R A; Le Pechoux, C; De Ruysscher, D (2022). Consolidation nivolumab and ipilimumab versus observation in limited-disease small-cell lung cancer after chemo-radiotherapy - results from the randomised phase II ETOP/ IFCT 4-12 STIMULI trial. Annals of Oncology, 33(1):67-79.
Cathomas, Richard; Lorch, Anja; Bruins, Harman M; Compérat, Eva M; Cowan, Nigel C; Efstathiou, Jason A; Fietkau, Rainer; Gakis, Georgios; Hernández, Virginia; Espinós, Estefania Linares; Neuzillet, Yann; Ribal, Maria J; Rouanne, Matthieu; Thalmann, George N; van der Heijden, Antoine G; Veskimäe, Erik; Alfred Witjes, J; Milowsky, Matthew I (2022). The 2021 Updated European Association of Urology Guidelines on Metastatic Urothelial Carcinoma. European Urology, 81(1):95-103.
Meihandoest, Tamana; Studt, Jan-Dirk; Mendez, Adriana; Alberio, Lorenzo; Fontana, Pierre; Wuillemin, Walter A; Schmidt, Adrian; Graf, Lukas; Gerber, Bernhard; Amstutz, Ursula; Bovet, Cédric; Sauter, Thomas C; Asmis, Lars M; Nagler, Michael (2022). Accuracy of a Single, Heparin-Calibrated Anti-Xa Assay for the Measurement of Rivaroxaban, Apixaban, and Edoxaban Drug Concentrations: A Prospective Cross-Sectional Study. Frontiers in cardiovascular medicine, 9:817826.
62
Meloni, Claudia. Characterization of a single center acute myeloid leukemia patient cohort treated with an intensive regimen. 2022, University of Zurich, Medizinische Fakultät.
Ring, Alexander; Spataro, Maria; Wicki, Andreas; Aceto, Nicola (2022). Clinical and Biological Aspects of Disseminated Tumor Cells and Dormancy in Breast Cancer. Frontiers in Cell and Developmental Biology, 10:929893.
Bischoff-Ferrari, Heike A; Willett, Walter C; Manson, JoAnn E; Dawson-Hughes, Bess; Manz, Markus G; Theiler, Robert; Braendle, Kilian; Vellas, Bruno; Rizzoli, René; Kressig, Reto W; Staehelin, Hannes B; da Silva, José A P; Armbrecht, Gabriele; Egli, Andreas; Kanis, John A; Orav, Endel J; Gaengler, Stephanie (2022). Combined Vitamin D, Omega-3 Fatty Acids, and a Simple Home Exercise Program May Reduce Cancer Risk Among Active Adults Aged 70 and Older: A Randomized Clinical Trial. Frontiers in Aging, 3:852643.
Tettero, Jesse M; Al-Badri, Waleed K W; Ngai, Lok Lam; Bachas, Costa; Breems, Dimitri A; van Elssen, Catharina H M J; Fischer, Thomas; Gjertsen, Bjorn T; van Gorkom, Gwendolyn N Y; Gradowska, Patrycja; Greuter, Marjolein J E; Griskevicius, Laimonas; Juliusson, Gunnar; Maertens, Johan; Manz, Markus G; Pabst, Thomas; Passweg, Jakob; Porkka, Kimmo; Löwenberg, Bob; Ossenkoppele, Gert J; Janssen, Jeroen J W M; Cloos, Jacqueline (2022). Concordance in measurable residual disease result after first and second induction cycle in acute myeloid leukemia: An outcome- and cost-analysis. Frontiers in Oncology, 12:999822.
Šuipytė, Jorūnė. Does progress achieved in treatment of patients with metastatic non-small-cell lung cancer (NSCLC) reach the elderly population? 2022, University of Zurich, Medizinische Fakultät.
Christiansen, Ailsa J; Lobo, João; Fankhauser, Christian Daniel; Rothermundt, Christian; Cathomas, Richard; Batavia, Aashil A; Grogg, Josias B; Templeton, Arnoud J; Hirschi-Blickenstorfer, Anita; Lorch, Anja; Gillessen, Silke; Moch, Holger; Beyer, Jörg; Hermanns, Thomas (2022). Impact of differing methodologies for serum miRNA-371a-3p assessment in stage I testicular germ cell cancer recurrence. Frontiers in Oncology, 12:1056823.
Wegener, Nadija; Balabanov, Stefan (2022). Klinische Zeichen eines myelodysplastischen Syndroms. Therapeutische Umschau. Revue thérapeutique, 78(2):71-75.
Schwab, Fabienne D; Scheidmann, Manuel C; Ozimski, Lauren L; Kling, André; Armbrecht, Lucas; Ryser, Till; Krol, Ilona; Strittmatter, Karin; Nguyen-Sträuli, Bich Doan; Jacob, Francis; Fedier, André; Heinzelmann-Schwarz, Viola; Wicki, Andreas; Dittrich, Petra S; Aceto, Nicola (2022). MyCTC chip: microfluidic-based drug screen with patient-derived tumour cells from liquid biopsies. Microsystems & Nanoengineering, 8:130.
Hofer, Kevin. Real-world outcomes in elderly ALL patients with and without allogeneic hematopoietic stem cell transplantation: a single-center evaluation over 10 years. 2022, University of Zurich, Medizinische Fakultät.
Schmid, Severin; Becker, Heiko; Fritsch, Ralph; Bausch, Johannes; Hunter, Natalie; Jenkner, Carolin; Hassan, Mohamed; Passlick, Bernward (2022). Study Protocol for a Randomised Controlled Trial on Pulmonary Metastasectomy vs. Standard of Care in Colorectal Cancer Patients With ≥ 3 Lung Metastases (PUCC-Trial). Frontiers in Oncology, 12:913896.
Akhoundova, Dilara; Haberecker, Martina; Fritsch, Ralph; Höller, Sylvia; Kiessling, Michael K; Rechsteiner, Markus; Rüschoff, Jan H; Curioni-Fontecedro, Alessandra (2022). Targeting ALK in Neuroendocrine Tumors of the Lung. Frontiers in Oncology, 12:911294.
Moretti, Alex; Ponzo, Marianna; Nicolette, Charles A; Tcherepanova, Irina Y; Biondi, Andrea; Magnani, Chiara F (2022). The Past, Present, and Future of Non-Viral CAR T Cells. Frontiers in Immunology, 13:867013.
2023
Menchinskaya, Ekaterina S; Dyshlovoy, Sergey A; Venz, Simone; Jacobsen, Christine; Hauschild, Jessica; Rohlfing, Tina; Silchenko, Aleksandra S; Avilov, Sergey A; Balabanov, Stefan; Bokemeyer, Carsten; Aminin, Dmitry L; von Amsberg, Gunhild; Honecker, Friedemann (2023). Anticancer Activity of the Marine Triterpene Glycoside Cucumarioside A2-2 in Human Prostate Cancer Cells. Marine Drugs, 22(1):20.
Miller, Peter Grant; Sperling, Adam S; Mayerhofer, Christina; McConkey, Marie E; Ellegast, Jana Maria; Da Silva, Carmen; Cohen, Drew Nathaniel; Wang, Chuqi; Sharda, Azeem; Yan, Ni; Saha, Subha; Schluter, Cameron; Schechter, Ilexa; Słabicki, Mikołaj; Sandoval, Brittany; Kahn, Josephine; Boettcher, Steffen; Gibson, Christopher J; Scadden, David T; Stegmaier, Kimberly; Bhatt, Shruti; Lindsley, R Coleman; Ebert, Benjamin L (2023). PPM1D modulates hematopoietic cell fitness and response to DNA damage and is a therapeutic target in myeloid malignancy. Blood, 142(24):2079-2091.
Saito, Yasuyuki; Iida-Norita, Rie; Afroj, Tania; Refaat, Alaa; Hazama, Daisuke; Komori, Satomi; Ohata, Shinya; Takai, Tomoko; Oduori, Okechi S; Kotani, Takenori; Funakoshi, Yohei; Koma, Yu-Ichiro; Murata, Yoji; Yakushijin, Kimikazu; Matsuoka, Hiroshi; Minami, Hironobu; Yokozaki, Hiroshi; Manz, Markus G; Matozaki, Takashi (2023). Preclinical evaluation of the efficacy of an antibody to human SIRPα for cancer immunotherapy in humanized mouse models. Frontiers in Immunology, 14:1294814.
Wilk, C Matthias; Cathomas, Flurin; Török, Orsolya; Le Berichel, Jessica; Park, Matthew D; Bigenwald, Camille; Heaton, George R; Hamon, Pauline; Troncoso, Leanna; Scull, Brooks P; Dangoor, Diana; Silvin, Aymeric; Fleischmann, Ryan; Belabed, Meriem; Lin, Howard; Merad Taouli, Elias; Boettcher, Steffen; Li, Long; Aubry, Antonio; Manz, Markus G; Kofler, Julia K; Yue, Zhenyu; Lira, Sergio A; Ginhoux, Florent; Crary, John F; McClain, Kenneth L; Picarsic, Jennifer L; Russo, Scott J; Allen, Carl E; Merad, Miriam (2023). Circulating senescent myeloid cells infiltrate the brain and cause neurodegeneration in histiocytic disorders. Immunity, 56(12):27902802.e6.
Nadeu, Ferran; Syrykh, Charlotte; Pons-Brun, Berta; Russiñol, Núria; Playa-Albinyana, Heribert; Baumann, Tycho Stephan; Duran-Ferrer, Martí; Kulis, Marta; Carbó-Meix, Anna; Mozas, Pablo; Alcoceba, Miguel; González, Marcos; Navarro-Bailón, Almudena; Colado, Enrique; Payer, Ángel; Aymerich, Marta; Terol, María José; Lu, Junyan; Knisbacher, Binyamin Asher; Hahn, Cynthia K; Ruiz-Gaspà, Sílvia; Enjuanes, Anna; Wu, Catherine J; Getz, Gad; Zenz, Thorsten; López-Guillermo, Armando; Martin-Subero, Jose I; Colomer, Dolors; Delgado, Julio; Campo, Elías (2023). IGLV321R110 mutation has prognostic value in patients with treatmentnaive chronic lymphocytic leukemia. Blood Advances, 7(23):73847391.
Volta, Laura; Manz, Markus G (2023). Twisted: Escape of epitope-edited healthy cells from immune attack. Journal of Experimental Medicine, 220(12):e20231635.
von der Grün, Jens; Ahmadsei, Maiwand; Breyer, Isabel; Britschgi, Christian; Eberli, Daniel; Hermanns, Thomas; Mangana, Joanna; Petrowsky, Henrik; Ramelyte, Egle; Roth, Patrick; Schär, Gabriel; Opitz, Isabelle; Weller, Michael; Wicki, Andreas; Witzel, Isabell; Balermpas, Panagiotis; Guckenberger, Matthias (2023). Patient recruitment into clinical studies of solid malignancies during the COVID-19 pandemic in a tertiary cancer center. Neoplasia, 46:100946.
63
Tettero, Jesse M; Buisman, Yara; Ngai, Lok Lam; Bachas, Costa; Gjertsen, Bjorn T; Kelder, Angèle; van de Loosdrecht, Arjan A; Manz, Markus G; Pabst, Thomas; Scholten, Willemijn; Ossenkoppele, Gert J; Cloos, Jacqueline; de Leeuw, David C (2023). Prognostic Significance of Measurable Residual Disease Detection by Flow Cytometry in Autologous Stem Cell Apheresis Products in AML. HemaSphere, 7(12):e981.
Chamuleau, Martine E D; Stenner, Frank; Chitu, Dana A; Novak, Urban; Minnema, Monique C; Geerts, Paul; Stevens, Wendy B C; Zenz, Thorsten; van Imhoff, Gustaaf W; Wu, Ka Lung; Demandt, Astrid M P; Kersten, Marie Jose; Terpstra, Wim E; Tick, Lidwine W; Deeren, Dries; Van Den Neste, Eric; Gregor, Michael; Veelken, Hendrik; Böhmer, Lara H; Caspar, Clemens B; Mutsaers, Pim; Refos, Jeannine M; Sewsaran, Robby; Fu, Liping; Seefat, Rianne L; Uyl-de Groot, Carin A; Dirnhofer, Stefan; Van Den Brand, Michiel; de Jong, Daphne; Nijland, Marcel; et al (2023). R-CODOXM/R-IVAC versus DA-EPOCH-R in patients with newly diagnosed Burkitt lymphoma (HOVON/SAKK): final results of a multicentre, phase 3, open-label, randomised trial. The Lancet Haematology, 10(12):e966-e975.
Nishida, Yuki; Ishizawa, Jo; Ayoub, Edward; Montoya, Rafael Heinz; Ostermann, Lauren B; Muftuoglu, Muharrem; Ruvolo, Vivian R; Patsilevas, Tallie; Scruggs, Darah A; Khazaei, Shayaun; Mak, Po Yee; Tao, Wenjing; Carter, Bing Z; Boettcher, Steffen; Ebert, Benjamin L; Daver, Naval G; Konopleva, Marina; Seki, Takahiko; Kojima, Kensuke; Andreeff, Michael (2023). Enhanced TP53 reactivation disrupts MYC transcriptional program and overcomes venetoclax resistance in acute myeloid leukemias. Science Advances, 9(48):eadh1436.
Djerbi, Nadia; Zimmermann, Kathrin; Roncador, Marco; Becker, Mike Oliver; Manz, Markus G; Balabanov, Stefan (2023). Intrapatient competition of VEXAS syndrome and CML clones. Blood Advances, 7(22):6815-6818.
Glüge, Stefan; Balabanov, Stefan; Koelzer, Viktor Hendrik; Ott, Thomas (2023). Evaluation of deep learning training strategies for the classification of bone marrow cell images. Computer Methods and Programs in Biomedicine, 243:107924.
Grünwald, Viktor; Ivanyi, Philipp; Zschäbitz, Stefanie; Wirth, Manfred; Staib, Peter; Schostak, Martin; Dargatz, Philip; Müller, Lothar; Metz, Michael; Bergmann, Lothar; Steiner, Thomas; Welslau, Martin; Lorch, Anja; Rafiyan, Reza; Hellmis, Eva; Darr, Cristopher; Schütt, Philipp; Meiler, Johannes; Kretz, Thomas; Loidl, Wolfgang; Flörcken, Anne; Mänz, Martin; Hinke, Axel; Hartmann, Arndt; Grüllich, Carsten (2023). Nivolumab Switch Maintenance Therapy After Tyrosine Kinase Inhibitor Induction in Metastatic Renal Cell Carcinoma: A Randomized Clinical Trial by the Interdisciplinary Working Group on Renal Tumors of the German Cancer Society (NIVOSWITCH; AIO-NZK-0116ass). European Urology, 84(6):571-578.
Pavic, Matea; Wolfer, Anita; Li, Qiyu; Gircys, Arunas; Juritz, Stephanie; Wicki, Andreas; Cerny, Thomas; Rohr, Ulrich-Peter (2023). Regulatory Challenges: Is a Surrogate End Point Instead of Overall Survival Enough for Regulatory Approval of (Neo)Adjuvant Cancer Treatment? The Swissmedic Perspective. Journal of Clinical Oncology, 41(32):4973-4975.
Hänsch, Lena; Peipp, Matthias; Mastall, Maximilian; Villars, Danielle; Myburgh, Renier; Silginer, Manuela; Weiss, Tobias; Gramatzki, Dorothee; Vasella, Flavio; Manz, Markus G; Weller, Michael; Roth, Patrick (2023). Chimeric antigen receptor T cellbased targeting of CD317 as a novel immunotherapeutic strategy against glioblastoma. Neuro-Oncology, 25(11):2001-2014.
Pabst, Thomas; Papayannidis, Cristina; Demirkan, Fatih; Doronin, Vadim; Fogliatto, Laura M; Guttke, Christina; Gyan, Emmanuel; Hamad, Nada; Herrera, Pilar; Hultberg, Anna; Jacobs, Julie; Johnson,
Amy J; Langlois, Angélique; Ma, Xuewen; Martinelli, Giovanni; Arnan, Montserrat; Müller, Rouven; Nottage, Kerri; Ofran, Yishai; Özcan, Muhit; Samoilova, Olga; Tolbert, Jaszianne A; Trudel, Géralyn C; Xiu, Liang; Vey, Norbert; Wei, Andrew H (2023). Cusatuzumab plus azacitidine in newly diagnosed acute myeloid leukaemia ineligible for intensive chemotherapy (CULMINATE): part one of a randomised, phase 2, dose optimisation study. The Lancet Haematology, 10(11):e902-e912.
Rha, Sun Young; Oh, Do-Youn; Yañez, Patricio; Bai, Yuxian; Ryu, Min-Hee; Lee, Jeeyun; Rivera, Fernando; Alves, Gustavo Vasconcelos; Garrido, Marcelo; Shiu, Kai-Keen; Fernández, Manuel González; Li, Jin; Lowery, Maeve A; Çil, Timuçin; Cruz, Felipe Melo; Qin, Shukui; Luo, Suxia; Pan, Hongming; Wainberg, Zev A; Yin, Lina; Bordia, Sonal; Bhagia, Pooja; Wyrwicz, Lucjan S; KEYNOTE-859 investigators; Fritsch, Ralph (2023). Pembrolizumab plus chemotherapy versus placebo plus chemotherapy for HER2-negative advanced gastric cancer (KEYNOTE-859): a multicentre, randomised, double-blind, phase 3 trial. Lancet Oncology, 24(11):1181-1195.
Ecker, Veronika; Brandmeier, Lisa; Stumpf, Martina; Giansanti, Piero; Moreira, Aida Varela; Pfeuffer, Lisa; Fens, Marcel H A M; Lu, Junyan; Kuster, Bernhard; Engleitner, Thomas; Heidegger, Simon; Rad, Roland; Ringshausen, Ingo; Zenz, Thorsten; Wendtner, Clemens-Martin; Müschen, Markus; Jellusova, Julia; Ruland, Jürgen; Buchner, Maike (2023). Negative feedback regulation of MAPK signaling is an important driver of chronic lymphocytic leukemia progression. Cell Reports, 42(10):113017.
Sarvan, Milos; Etienne, Harry; Bankel, Lorenz; Brown, Michelle L; Schneiter, Didier; Opitz, Isabelle (2023). Outcome Analysis of Treatment Modalities for Thoracic Sarcomas. Cancers, 15(21):5154. Germans, Menno R; Rohr, Jonas; Globas, Christoph; Schubert, Tilman; Kaserer, Alexander; Brandi, Giovanna; Studt, JanDirk; Greutmann, Matthias; Geiling, Katharina; Verweij, Lotte; Regli, Luca (2023). Challenges in Coagulation Management in Neurosurgical Diseases: A Scoping Review, Development, and Implementation of Coagulation Management Strategies. Journal of Clinical Medicine, 12(20):6637.
Wildschut, Mattheus H E; Mena, Julien; Dördelmann, Cyril; van Oostrum, Marc; Hale, Benjamin D; Settelmeier, Jens; Festl, Yasmin; Lysenko, Veronika; Schürch, Patrick M; Ring, Alexander; Severin, Yannik; Bader, Michael S; Pedrioli, Patrick G A; Goetze, Sandra; van Drogen, Audrey; Balabanov, Stefan; Skoda, Radek C; Lopes, Massimo; Wollscheid, Bernd; Theocharides, Alexandre P A ; Snijder, Berend (2023). Proteogenetic drug response profiling elucidates targetable vulnerabilities of myelofibrosis. Nature Communications, 14(1):6414.
Wilk, C Matthias; Cathomas, Flurin; Török, Orsolya; Le Berichel, Jessica; Park, Matthew D; Heaton, George R; Hamon, Pauline; Troncoso, Leanna; Scull, Brooks P; Dangoor, Diana; Silvin, Aymeric; Fleischmann, Ryan; Belabed, Meriem; Lin, Howard; Taouli, Elias Merad; Boettcher, Steffen; Manz, Markus G; Kofler, Julia K; Yue, Zhenyu; Lira, Sergio A; Ginhoux, Florent; Crary, John F; McClain, Kenneth L; Picarsic, Jennifer L; Russo, Scott J; Allen, Carl E; Merad, Miriam (2023). Circulating senescent myeloid cells drive blood brain barrier breakdown and neurodegeneration. bioRxiv 561744, University of Zurich.
Herbst, Sophie A; Kim, Vladislav; Roider, Tobias; Schitter, Eva C; Bruch, Peter-Martin; Liebers, Nora; Kolb, Carolin; Knoll, Mareike; Lu, Junyan; Dreger, Peter; Müller-Tidow, Carsten; Zenz, Thorsten; Huber, Wolfgang; Dietrich, Sascha (2023). Comparing the value of mono- vs coculture for high-throughput compound screening in hematological malignancies. Blood Advances, 7(19):5925-5936.
64
Liebers, Nora; Bruch, Peter-Martin; Terzer, Tobias; Hernandez-Hernandez, Miguel; Paramasivam, Nagarajan; Fitzgerald, Donnacha; Altmann, Heidi; Roider, Tobias; Kolb, Carolin; Knoll, Mareike; Lenze, Angela; Platzbecker, Uwe; Röllig, Christoph; Baldus, Claudia; Serve, Hubert; Bornhäuser, Martin; Hübschmann, Daniel; Müller-Tidow, Carsten; Stölzel, Friedrich; Huber, Wolfgang; Benner, Axel; Zenz, Thorsten; Lu, Junyan; Dietrich, Sascha (2023). Ex vivo drug response profiling for response and outcome prediction in hematologic malignancies: the prospective non-interventional SMARTrial. Nature Cancer, 4(12):1648-1659.
Buljan, Marija; Banaei-Esfahani, Amir; Blattmann, Peter; MeierAbt, Fabienne; Shao, Wenguang; Vitek, Olga; Tang, Hua; Aebersold, Ruedi (2023). A computational framework for the inference of protein complex remodeling from whole-proteome measurements. Nature Methods, 20(10):1523-1529.
Rieger, Max J; Schenkel, Xenia; Dedic, Ivona; Brunn, Tadeusz; Gnannt, Ralph; Hofmann, Michael; de Rougemont, Olivier; Stolz, Sebastian M; Rösler, Wiebke; Studt, Jan-Dirk; Balabanov, Stefan; Wicki, Andreas; Lorch, Anja; Manz, Markus G; Schwotzer, Rahel (2023). Complication rates of peripherally inserted central catheters vs implanted ports in patients receiving systemic anticancer therapy: A retrospective cohort study. International Journal of Cancer, 153(7):1397-1405.
Tettero, Jesse M; Ngai, Lok Lam; Bachas, Costa; Breems, Dimitri A; Fischer, Thomas; Gjertsen, Bjorn T; Gradowska, Patrycja; Griskevicius, Laimonas; Janssen, Jeroen J W M; Juliusson, Gunnar; Maertens, Johan; Manz, Markus G; Pabst, Thomas; Passweg, Jakob; Porkka, Kimmo; Valk, Peter J M; Löwenberg, Bob; Ossenkoppele, Gert J; Cloos, Jacqueline (2023). Measurable residual disease-guided therapy in intermediate-risk acute myeloid leukemia patients is a valuable strategy in reducing allogeneic transplantation without negatively affecting survival. Haematologica, 108(10):2794-2798.
Lütge, Almut; Lu, Junyan; Hüllein, Jennifer; Walther, Tatjana; Sellner, Leopold; Wu, Bian; Rosenquist, Richard; Oakes, Christopher C; Dietrich, Sascha; Huber, Wolfgang; Zenz, Thorsten (2023). Subgroup-specific gene expression profiles and mixed epistasis in chronic lymphocytic leukemia. Haematologica, 108(10):26642676.
Marques-Maggio, Ewerton; Maccio, Umberto; Marx, Alexandra; Galli, Serena; Schwab, Nathalie; Frank, Angela; Hamelin, Baptiste; Varga, Zsuzsanna; Nombela-Arrieta, César; Mertz, Kirsten D; Theocharides, Alexandre Pa; Koelzer, Viktor H (2023). Bone marrow haematopoiesis in patients with COVID-19. Histopathology, 83(4):582-590.
Stricker, Helena Marie; Wicki, Andreas (2023). Langzeitnebenwirkungen der Immuncheckpoint-Inhibitoren. Therapeutische Umschau : Monatsschrift für praktische Medizin, 80(8):367-372.
Fischer, Jacqueline; Erkner, Estelle; Fitzel, Rahel; Radszuweit, Pia; Keppeler, Hildegard; Korkmaz, Fulya; Roti, Giovanni; Lengerke, Claudia; Schneidawind, Dominik; Schneidawind, Corina (2023). Uncovering NOTCH1 as a Promising Target in the Treatment of MLL-Rearranged Leukemia. International Journal of Molecular Sciences, 24(19):14466.
Magnani, Chiara F; Myburgh, Renier; Brunn, Silvan; Chambovey, Morgane; Ponzo, Marianna; Volta, Laura; Manfredi, Francesco; Pellegrino, Christian; Pascolo, Steve; Miskey, Csaba; Ivics, Zoltán; Shizuru, Judith A; Neri, Dario; Manz, Markus G (2023). Anti-CD117 CAR T cells incorporating a safety switch eradicate human acute myeloid leukemia and hematopoietic stem cells. Molecular Therapy : Oncolytics, 30:56-71.
Carter, Bing Z; Mak, Po Yee; Muftuoglu, Muharrem; Tao, Wenjing; Ke, Baozhen; Pei, Jingqi; Bedoy, Andrea D; Ostermann, Lauren B; Nishida, Yuki; Isgandarova, Sevinj; Sobieski, Mary; Nguyen, Nghi; Powell, Reid T; Martinez-Moczygemba, Margarita; Stephan, Clifford; Basyal, Mahesh; Pemmaraju, Naveen; Boettcher, Steffen; Ebert, Benjamin L; Shpall, Elizabeth J; Wallner, Barbara; Morgan, Robert A; Karras, Georgios I; Moll, Ute M; Andreeff, Michael (2023). Epichaperome inhibition targets TP53-mutant AML and AML stem/progenitor cells. Blood, 142(12):1056-1070.
Maru, Bruktawit; Messikommer, Alessandra; Huang, Linhui; Seipel, Katja; Kovecses, Olivia; Valk, Peter J M; Theocharides, Alexandre P A ; Mercier, Francois E; Pabst, Thomas; McKeague, Maureen; Luedtke, Nathan W (2023). PARP-1 improves leukemia outcomes by inducing parthanatos during chemotherapy. Cell Reports Medicine, 4(9):101191.
Speicher, Philip; Fankhauser, Christian D; Lorch, Anja; Ardizzone, Davide; Helnwein, Simon; Hoch, Dennis; Hermanns, Thomas; Beyer, Jörg; Akhoundova, Dilara (2023). Excellent survival in relapsed stage I testicular cancer. BMC Cancer, 23(1):870.
Bonini, Chiara; Chapuis, Aude G; Hudecek, Michael; Guedan, Sonia; Magnani, Chiara; Qasim, Waseem (2023). Genome Editing in Engineered T Cells for Cancer Immunotherapy. Human Gene Therapy, 34(17-18):853-869.
Rejeski, Kai; Subklewe, Marion; Aljurf, Mahmoud; Bachy, Emmanuel; Balduzzi, Adriana; Barba, Pere; Bruno, Benedetto; Benjamin, Reuben; Carrabba, Matteo G; Chabannon, Christian; Ciceri, Fabio; Corradini, Paolo; Delgado, Julio; Di Blasi, Roberta; Greco, Raffaella; Houot, Roch; Iacoboni, Gloria; Jäger, Ulrich; Kersten, Marie José; Mielke, Stephan; Nagler, Arnon; Onida, Francesco; Peric, Zinaida; Roddie, Claire; Ruggeri, Annalisa; Sánchez-Guijo, Fermín; Sánchez-Ortega, Isabel; Schneidawind, Dominik; Schubert, Maria-Luisa; Snowden, John A; et al (2023). Immune effector cell-associated hematotoxicity: EHA/EBMT consensus grading and best practice recommendations. Blood, 142(10):865-877.
Cefalì, Marco; Scala, Isabel; Pavone, Giuliana; Helbling, Daniel; Hussung, Saskia; Fritsch, Ralph; Reiner, Cäcilia; Stocker, Soleen; Koeberle, Dieter; Kissling, Marc; Chianca, Vito; Del Grande, Filippo; De Dosso, Sara; Rizzo, Stefania (2023). Is Computed-Tomography-Based Body Composition a Reliable Predictor of Chemotherapy-Related Toxicity in Pancreatic Cancer Patients? Cancers, 15(17):4398.
Lauinger, Manuel; Christen, Daniel; Klar, Rhena F U; Roubaty, Carole; Heilig, Christoph E; Stumpe, Michael; Knox, Jennifer J; Radulovich, Nikolina; Tamblyn, Laura; Xie, Irene Y; Horak, Peter; Forschner, Andrea; Bitzer, Michael; Wittel, Uwe A; Boerries, Melanie; Ball, Claudia R; Heining, Christoph; Glimm, Hanno; Fröhlich, Martina; Hübschmann, Daniel; Gallinger, Steven; Fritsch, Ralph; Fröhling, Stefan; O’Kane, Grainne M; Dengjel, Jörn; Brummer, Tilman (2023). BRAFΔβ 3− α C in-frame deletion mutants differ in their dimerization propensity, HSP90 dependence, and druggability. Science Advances, 9(35):eade7486.
Fritsch, Ralph; Hempel, Chiara Louisa (2023). Intensification and Personalization of Neoadjuvant Therapy for Locally Advanced Rectal Cancer. Praxis, 112(11):537.
Hammerer-Lercher, Angelika; Nilius, Henning; Studt, Jan-Dirk; Tsakiris, Dimitrios A; Greinacher, Andreas; Mendez, Adriana; Schmidt, Adrian; Wuillemin, Walter A; Gerber, Bernhard; Kremer Hovinga, Johanna A; Vishnu, Prakash; Graf, Lukas; Bakchoul, Tamam; Nagler, Michael (2023). Limited concordance of heparin/platelet factor 4 antibody assays for the diagnosis of heparin-induced thrombocytopenia: an analysis of the TORADI-HIT study. Journal of Thrombosis and Haemostasis, 21(9):2559-2568.
65
Templeton, Arnoud J; Omlin, Aurelius; Berthold, Dominik; Beyer, Jörg; Burger, Irene A; Eberli, Daniel; Engeler, Daniel; Fankhauser, Christian; Fischer, Stefanie; Gillessen, Silke; Nicolas, Guillaume; Kroeze, Stephanie; Lorch, Anja; Müntener, Michael; Papachristofilou, Alexandros; Schaefer, Niklaus; Seiler, Daniel; Stenner, Frank; Tsantoulis, Petros; Vlajnic, Tatjana; Zilli, Thomas; Zwahlen, Daniel; Cathomas, Richard (2023). Interdisciplinary Swiss consensus recommendations on staging and treatment of advanced prostate cancer. Swiss Medical Weekly, 153(8):40108.
von Stauffenberg, Franz; Hegemann, Inga; Schwotzer, Rahel; Lehmann, Kuno; Widmer, Jeannette (2023). Management of abdominal pseudotumours in haemophilia: a systematic review. Swiss Medical Weekly, 153(8):40094.
Hoch, Dennis; Helnwein, Simon; Adrizzone, Davide; Lorch, Anja; Fankhauser, Christian; Hermanns, Thomas; Thalmann, George; Beyer, Jörg (2023). No Survival Differences among GermCell Cancer Patients from Urban and Rural Areas. Oncology Research and Treatment, 46(10):433-437. Carbo-Meix, Anna; Guijarro, Francesca; Wang, Luojun; Grau, Marta; Royo, Romina; Frigola, Gerard; Playa-Albinyana, Heribert; Bühler, Marco M; Clot, Guillem; Duran-Ferrer, Marti; Lu, Junyan; Granada, Isabel; Baptista, Maria-Joao; Navarro, Jose-Tomas; Espinet, Blanca; Puiggros, Anna; Tapia, Gustavo; Bandiera, Laura; De Canal, Gabriella; Bonoldi, Emanuela; Climent, Fina; Ribera-Cortada, Inmaculada; Fernandez-Caballero, Mariana; De la Banda, Esmeralda; Do Nascimento, Janilson; Pineda, Alberto; Vela, Dolors; Rozman, Maria; Aymerich, Marta; Syrykh, Charlotte; Zenz, Thorsten; et al (2023). BCL3-rearrangements in B-cell lymphoid neoplasms occur in two breakpoint clusters associated with different diseases. Haematologica, 109(2):493-508. Grockowiak, Elodie; Korn, Claudia; Rak, Justyna; Lysenko, Veronika; Hallou, Adrien; Panvini, Francesca M; Williams, Matthew; Fielding, Claire; Fang, Zijian; Khatib-Massalha, Eman; García-García, Andrés; Li, Juan; Khorshed, Reema A; González-Antón, Sara; Baxter, E Joanna; Kusumbe, Anjali; Wilkins, Bridget S; Green, Anna; Simons, Benjamin D; Harrison, Claire N; Green, Anthony R; Lo Celso, Cristina; Theocharides, Alexandre P A ; Méndez-Ferrer, Simón (2023). Different niches for stem cells carrying the same oncogenic driver affect pathogenesis and therapy response in myeloproliferative neoplasms. Nature Cancer, 4(8):1193-1209.
Ni, Ruiqing; Straumann, Nadja; Fazio, Serana; Dean-Ben, Xose Luis; Louloudis, Georgios; Keller, Claudia; Razansky, Daniel; Ametamey, Simon; Mu, Linjing; Nombela-Arrieta, César; Klohs, Jan (2023). Imaging increased metabolism in the spinal cord in mice after middle cerebral artery occlusion. Photoacoustics, 32:100532.
Angelillo-Scherrer, Anne; Casini, Alessandro; Studt, Jan-Dirk; Gerber, Bernhard; Alberio, Lorenzo A; Fontana, Pierre (2023). Recommendations for the use of andexanet alfa in the management of bleeding in patients on oral factor Xa inhibitors in Switzerland: Guideline from the Working Party Hemostasis of the Swiss Society of Hematology. Swiss Medical Weekly, 153:40113.
Rieger, Max J; Stolz, Sebastian M; Müller, Antonia M; Schwotzer, Rahel; Nair, Gayathri; Schneidawind, Dominik; Manz, Markus G; Schanz, Urs (2023). Haploidentical transplant with posttransplant cyclophosphamide vs matched related and unrelated donor transplant in acute myeloid leukemia and myelodysplastic neoplasm. Bone Marrow Transplantation, 58(10):1121-1129.
Hiester, Andreas; Che, Yue; Lusch, Achim; Kuß, Oliver; Niegisch, Günter; Lorch, Anja; Arsov, Christian; Albers, Peter (2023). Phase 2 Single-arm Trial of Primary Retroperitoneal Lymph Node Dissection in Patients with Seminomatous Testicular Germ Cell Tumors with Clinical Stage IIA/B (PRIMETEST). European Urology, 84(1):25-31.
Pabst, Thomas; Vey, Norbert; Adès, Lionel; Bacher, Ulrike; Bargetzi, Mario; Fung, Samson; Gaidano, Gianluca; Gandini, Domenica; Hultberg, Anna; Johnson, Amy; Ma, Xuewen; Müller, Rouven; Nottage, Kerri; Papayannidis, Cristina; Recher, Christian; Riether, Carsten; Shah, Priya; Tryon, Jeffrey; Xiu, Liang; Ochsenbein, Adrian F (2023). Results from a phase I/II trial of cusatuzumab combined with azacitidine in patients with newly diagnosed acute myeloid leukemia who are ineligible for intensive chemotherapy. Haematologica, 108(7):1793-1802.
Fitzel, Rahel; Secker-Grob, Kathy-Ann; Keppeler, Hildegard; Korkmaz, Fulya; Schairer, Rebekka; Erkner, Estelle; Schneidawind, Dominik; Lengerke, Claudia; Hentrich, Thomas; Schulze-Hentrich, Julia M; Schneidawind, Corina (2023). Targeting MYC in combination with epigenetic regulators induces synergistic anti-leukemic effects in MLLr leukemia and simultaneously improves immunity. Neoplasia, 41:100902.
Marion, William; Koppe, Tiago; Chen, Chun-Chin; Wang, Dahai; Frenis, Katie; Fierstein, Sara; Sensharma, Prerana; Aumais, Olivia; Peters, Michael; Ruiz-Torres, Sonya; Chihanga, Tafadzwa; Boettcher, Steffen; Shimamura, Akiko; Bauer, Daniel E; Schlaeger, Thorsten; Wells, Susanne I; Ebert, Benjamin L; Starczynowski, Daniel; da Rocha, Edroaldo Lummertz; Rowe, R Grant (2023). RUNX1 mutations mitigate quiescence to promote transformation of hematopoietic progenitors in Fanconi anemia. Leukemia, 37(8):1698-1708.
Burger, Annika; Studt, Jan-Dirk; Mendez, Adriana; Alberio, Lorenzo; Fontana, Pierre; Wuillemin, Walter A; Schmidt, Adrian; Graf, Lukas; Gerber, Bernhard; Bovet, Cédric; Sauter, Thomas C; Binder, Nikolaus B; Nagler, Michael (2023). Determination of Anti-Xa Inhibitor Plasma Concentrations Using a Universal Edoxaban Calibrator. Diagnostics, 13(12):2128.
Hilberink, Jacobien R; van Zeventer, Isabelle A; Chitu, Dana A; Pabst, Thomas; Klein, Saskia K; Stussi, Georg; Griskevicius, Laimonas; Valk, Peter J M; Cloos, Jacqueline; van de Loosdrecht, Arjan A; Breems, Dimitri; van Lammeren-Venema, Danielle; Boersma, Rinske; Jongen-Lavrencic, Mojca; Fehr, Martin; Hoogendoorn, Mels; Manz, Markus G; Söhne, Maaike; van Marwijk Kooy, Rien; Deeren, Dries; van der Poel, Marjolein W M; Legdeur, Marie Cecile; Tick, Lidwine; Chalandon, Yves; Ammatuna, Emanuele; Blum, Sabine; Löwenberg, Bob; Ossenkoppele, Gert J; Dutch-Belgian Hemato-Oncology Cooperative Group (HOVON); Swiss Group for Clinical Cancer Research (SAKK); et al (2023). Age and sex associate with outcome in older AML and high risk MDS patients treated with 10-day decitabine. Blood Cancer Journal, 13(1):93.
Elsayed, Abdullah; Pellegrino, Christian; Plüss, Louis; Peissert, Frederik; Benz, Ramon; Ulrich, Franziska; Thorhallsdottir, Gudrun; Plaza, Sheila Dakhel; Villa, Alessandra; Mock, Jacqueline; Puca, Emanuele; De Luca, Roberto; Manz, Markus G; Halin, Cornelia; Neri, Dario (2023). Generation of a novel fully human non-superagonistic anti-CD28 antibody with efficient and safe T-cell co-stimulation properties. mAbs, 15(1):2220839.
Yan, Yuqian; López-Alcalde, Jesús; Zhang, Linxin; Siebenhüner, Alexander R; Witt, Claudia M; Barth, Jürgen (2023). Acupuncture for the prevention of chemotherapy-induced nausea and vomiting in cancer patients: A systematic review and meta-analysis. Cancer Medicine, 12(11):12504-12517.
Lysenko, Veronika; Schürch, Patrick M; Tuzlak, Selma; van Wijk, Nicole Wildner-Verhey ; Kovtonyuk, Larisa V; Becher, Burkhard; Manz, Markus G; Kreutmair, Stefanie; Theocharides, Alexandre P A (2023). Blocking the CD47-SIRPα interaction reverses the disease phenotype in a polycythemia vera mouse model. Leukemia, 37(6):1277-1286.
66
Mehra, Tarun; Dongre, Kanchan; Boesing, Maria; Frei, Patricia; Suenderhauf, Claudia; Zippelius, Alfred; Leuppi, Joerg D; Wicki, Andreas; Leuppi-Taegtmeyer, Anne B (2023). Pre-treatment comorbidities, C-reactive protein and eosinophil count, and immune-related adverse events as predictors of survival with checkpoint inhibition for multiple tumour entities. Cancer Medicine, 12(11):12253-12262.
Ngai, Lok Lam; Hanekamp, Diana; Janssen, Fleur; Carbaat-Ham, Jannemieke; Hofland, Maaike A M A; Fayed, Mona M H E; Kelder, Angèle; Oudshoorn-van Marsbergen, Laura; Scholten, Willemijn J; Snel, Alexander N; Bachas, Costa; Tettero, Jesse M; Breems, Dimitri A; Fischer, Thomas; Gjertsen, Bjørn T; Griškevičius, Laimonas; Juliusson, Gunnar; van de Loosdrecht, Arjan A; Maertens, Johan A; Manz, Markus G; Pabst, Thomas; Passweg, Jakob R; Porkka, Kimmo; Valk, Peter J M; Gradowska, Patrycja; Löwenberg, Bob; de Leeuw, David C; Janssen, Jeroen J W M; Ossenkoppele, Gert J; Cloos, Jacqueline (2023). Prospective validation of the prognostic relevance of CD34+CD38− AML stem cell frequency in the HOVON-SAKK132 trial. Blood, 141(21):2657-2661. Shao, Lijian; Paik, Na Yoon; Sanborn, Mark A; Bandara, Thilinie; Vijaykumar, Anjali; Sottoriva, Kilian; Rehman, Jalees; Nombela-Arrieta, César; Pajcini, Kostandin V (2023). Hematopoietic Jagged1 is a fetal liver niche factor required for functional maturation and engraftment of fetal hematopoietic stem cells. Proceedings of the National Academy of Sciences of the United States of America, 120(20):e2210058120.
Omlin, Aurelius; Cathomas, Richard; von Amsberg, Gunhild; Reuter, Christoph; Feyerabend, Susan; Loidl, Wolfgang; Boegemann, Martin; Lorch, Anja; Heidenreich, Axel; Tsaur, Igor; Larcher-Senn, Julian; Buck, Stefan A J; Mathijssen, Ron H J; Jaehde, Ulrich; Gillessen, Silke; Joerger, Markus (2023). Randomized Phase II Cabazitaxel Dose Individualization and Neutropenia Prevention Trial in Patients with Metastatic Castration-Resistant Prostate Cancer. Clinical Cancer Research, 29(10):1887-1893.
Barz, Malwine Jeanette; Behrmann, Lena; Capron, Danaëlle; Zuchtriegel, Gabriele; Steffen, Fabio D; Kunz, Leo; Zhang, Yang; Vermeerbergen, Iria Jimenez; Marovca, Blerim; Kirschmann, Moritz; Zech, Antonia; Nombela-Arrieta, Cesar; Ziegler, Urs; Schroeder, Timm; Bornhauser, Beat; Bourquin, Jean-Pierre (2023). B and T cell acute lymphoblastic leukemia evade chemotherapy at distinct sites in the bone marrow. Haematologica, 108(5):1244-1258.
Neuenschwander, Anne; Lonati, Chiara; Antonelli, Luca; Papachristofilou, Alexandros; Cathomas, Richard; Rothermundt, Christian; Templeton, Arnoud J; Gulamhusein, Aziz; Fischer, Stefanie; Gillessen, Silke; Hermanns, Thomas; Lorch, Anja; Mattei, Agostino; Fankhauser, Christian D (2023). Treatment Outcomes for Men with Clinical Stage II Nonseminomatous Germ Cell Tumours Treated with Primary Retroperitoneal Lymph Node Dissection: A Systematic Review. European Urology Focus, 9(3):541-546.
Kropivsek, Klara; Kachel, Paul; Goetze, Sandra; Wegmann, Rebekka; Festl, Yasmin; Severin, Yannik; Hale, Benjamin D; Mena, Julien; van Drogen, Audrey; Dietliker, Nadja; Tchinda, Joëlle; Wollscheid, Bernd; Manz, Markus G; Snijder, Berend (2023). Ex vivo drug response heterogeneity reveals personalized therapeutic strategies for patients with multiple myeloma. Nature Cancer, 4(5):734-753.
Menges, Dominik; Piatti, Michela C; Omlin, Aurelius; Cathomas, Richard; Benamran, Daniel; Fischer, Stefanie; Iselin, Christophe; Küng, Marc; Lorch, Anja; Prause, Lukas; Rothermundt, Christian; O’Meara Stern, Alix; Zihler, Deborah; Lippuner, Max; Braun, Julia; Cerny, Thomas; Puhan, Milo A (2023). Patient and General Population Preferences Regarding the Benefits and Harms of Treatment for Metastatic Prostate Cancer: A Discrete Choice Experiment. European Urology Open Science, 51:26-38.
van den Berg, Jana; Haslbauer, Jasmin D; Stalder, Anna K; Romanens, Anna; Mertz, Kirsten D; Studt, Jan-Dirk; Siegemund, Martin; Buser, Andreas; Holbro, Andreas; Tzankov, Alexandar (2023). Von Willebrand factor and the thrombophilia of severe COVID-19: in situ evidence from autopsies. Research and Practice in Thrombosis and Haemostasis, 7(4):100182.
Carter, Bing Z; Mak, Po Yee; Tao, Wenjing; Ayoub, Edward; Ostermann, Lauren B; Huang, Xuelin; Loghavi, Sanam; Boettcher, Steffen; Nishida, Yuki; Ruvolo, Vivian; Hughes, Paul E; Morrow, Phuong K; Haferlach, Torsten; Kornblau, Steven; Muftuoglu, Muharrem; Andreeff, Michael (2023). Combined inhibition of BCL-2 and MCL-1 overcomes BAX deficiency-mediated resistance of TP53-mutant acute myeloid leukemia to individual BH3 mimetics. Blood Cancer Journal, 13(1):57.
Ring, Alexander; Sieber, Wolfgang Alexander; Studt, JanDirk; Schuepbach, Reto A; Ganter, Christoph Camille; Manz, Markus Gabriel; Müller, Antonia Maria Susanne; David, Sascha (2023). Indications and Outcomes of Patients Receiving Therapeutic Plasma Exchange under Critical Care Conditions: A Retrospective Eleven-Year Single-Center Study at a Tertiary Care Center. Journal of Clinical Medicine, 12(8):2876.
Fiskus, Warren; Mill, Christopher P; Birdwell, Christine; Davis, John A; Das, Kaberi; Boettcher, Steffen; Kadia, Tapan M; DiNardo, Courtney D; Takahashi, Koichi; Loghavi, Sanam; Soth, Michael J; Heffernan, Tim; McGeehan, Gerard M; Ruan, Xinjia; Su, Xiaoping; Vakoc, Christopher R; Daver, Naval; Bhalla, Kapil N (2023). Targeting of epigenetic co-dependencies enhances anti-AML efficacy of Menin inhibitor in AML with MLL1-r or mutant NPM1. Blood Cancer Journal, 13(1):53.
Notarfrancesco, Marco; Fankhauser, Christian D; Lorch, Anja; Ardizzone, Davide; Helnwein, Simon; Hoch, Dennis; Hermanns, Thomas; Thalmann, George; Beyer, Jörg (2023). Perioperative complications and oncological outcomes of post-chemotherapy retroperitoneal lymph node dissection in patients with germ cell cancer at two high-volume university centres in Switzerland - a retrospective chart review. Swiss Medical Weekly, 153:40053.
Bankova, Andriyana K; Pasin, Chloé; Huang, Alice; Cicin-Sain, Caroline; Epp, Selina; Audigé, Annette; Mueller, Nicolas J; Nilsson, Jakob; Vilinovszki, Oliver; Nair, Gayathri; Wolfensberger, Nathan; Hockl, Philipp; Schanz, Urs; Trkola, Alexandra; Kouyos, Roger; Hasse, Barbara; Zinkernagel, Annelies S; Manz, Markus G; Abela, Irene A; Müller, Antonia M S (2023). Antibody response to a third SARS-CoV-2 vaccine dose in recipients of an allogeneic haematopoietic cell transplantation. British Journal of Haematology, 201(1):58-63.
Gagesch, Michael; Rösler, Wiebke; Bauernschmitt, Robert; Wilhelm, Markus J; Freystätter, Gregor (2023). Nutzen altersmedizinischer Abklärungen vor Operationen, Interventionen und onkologischen Therapien. Praxis, 112(5-6):340-347.
Laptseva, Natallia; Rossi, Valentina A; Sudano, Isabella; Schwotzer, Rahel; Ruschitzka, Frank; Flammer, Andreas J; Duru, Firat (2023). Arrhythmic Manifestations of Cardiac Amyloidosis: Challenges in Risk Stratification and Clinical Management. Journal of Clinical Medicine, 12(7):2581.
Bajka, Anahita; Muth, Daniel Rudolf; Wiest, Maximilian Robert Justus; Said, Sadiq; Rejdak, Magdalena; Sidhu, Sophia; Foa, Nastasia; Blaser, Frank; Barthelmes, Daniel; Toro, Mario Damiano; Souied, Eric H; Deuel, Jeremy Werner; Schlagenhauf, Patricia; Zweifel, Sandrine Anne (2023). Analysis of Optical Coherence Tomography (OCT) and Optical Coherence Tomography Angiography (OCTA) Parameters in Young Adults after SARSCoV-2 Infection (COVID-19) Compared with Healthy Young Controls. Diagnostics, 13(7):1283.
67
Rösler, Wiebke; Altenbuchinger, Michael; Baeßler, Bettina; Beissbarth, Tim; Beutel, Gernot; Bock, Robert; von Bubnoff, Nikolas; Eckardt, Jan-Niklas; Foersch, Sebastian; Loeffler, Chiara M L; Middeke, Jan Moritz; Mueller, Martha-Lena; Oellerich, Thomas; Risse, Benjamin; Scherag, André; Schliemann, Christoph; Scholz, Markus; Spang, Rainer; Thielscher, Christian; Tsoukakis, Ioannis; Kather, Jakob Nikolas (2023). An overview and a roadmap for artificial intelligence in hematology and oncology. Journal of Cancer Research and Clinical Oncology, 149(10):7997-8006.
Yamada, Yoshito; Nguyen, Tuan Thanh; Impellizzieri, Daniela; Mineura, Katsutaka; Shibuya, Rintaro; Gomariz, Alvaro; Haberecker, Martina; Nilsson, Jakob; Nombela-Arrieta, César; Jungraithmayr, Wolfgang; Boyman, Onur (2023). Biased IL-2 signals induce Foxp3-rich pulmonary lymphoid structures and facilitate longterm lung allograft acceptance in mice. Nature Communications, 14(1):1383.
Mamot, Christoph; Wicki, Andreas; Hasler-Strub, Ursula; Riniker, Salome; Li, Qiyu; Holer, Lisa; Bärtschi, Daniela; Zaman, Khalil; von Moos, Roger; Dedes, Konstantin J; Boos, Laura A ; Novak, Urban; Bodmer, Alexandre; Ritschard, Reto; Obermann, Ellen C; Tzankov, Alexandar; Ackermann, Christoph; Membrez-Antonioli, Véronique; Zürrer-Härdi, Ursina; Caspar, Clemens B; Deuster, Stefanie; Senn, Martin; Winterhalder, Ralph; Rochlitz, Christoph (2023). A multicenter phase II trial of anti-EGFR-immunoliposomes loaded with doxorubicin in patients with advanced triple negative breast cancer. Scientific Reports, 13(1):3705.
Guckenberger, Matthias; Guninski, Ricarda Stella; Hüllner, Martin; Kobe, Adrian; Schaser, KlausD; Wicki, Andreas (2023). Aktuelle interdisziplinäre Behandlung von Knochenmetastasen. Die Onkologie, 29(3):222-229.
Benoit, Tobias Matthieu; Gundermann, Stefan (2023). Teufel mit Engelsflügeln – wenn Vitamin A Leben rettet. Deutsche Medizinische Wochenschrift, 148(7):396-399.
Caiado, Francisco; Kovtonyuk, Larisa V; Gonullu, Nagihan G; Fullin, Jonas; Boettcher, Steffen; Manz, Markus G (2023). Aging drives Tet2+/− clonal hematopoiesis via IL-1 signaling. Blood, 141(8):886903.
Planas-Paz, Lara; Pliego-Mendieta, Alicia; Hagedorn, Catherine; Aguilera-Garcia, Domingo; Haberecker, Martina; Arnold, Fabian; Herzog, Marius; Bankel, Lorenz; Guggenberger, Roman; Steiner, Sabrina; Chen, Yanjiang; Kahraman, Abdullah; Zoche, Martin; Rubin, Mark A; Moch, Holger; Britschgi, Christian; Pauli, Chantal (2023). Unravelling homologous recombination repair deficiency and therapeutic opportunities in soft tissue and bone sarcoma. EMBO Molecular Medicine:e16863.
Isenegger, Larissa Viviana . Phenotypic and Functional Validation of an in vitro Candidate Kinase Inhibitor Screen in Clear Cell Sarcoma. 2023, University of Zurich, Medizinische Fakultät.
Konrat, Judith; Rösler, Wiebke; Roiss, Michael; Meier-Abt, Fabienne; Widmer, Corinne C; Balabanov, Stefan; Manz, Markus G; Zenz, Thorsten (2023). BRAF inhibitor treatment of classical hairy cell leukemia allows successful vaccination against SARSCoV-2. Annals of Hematology, 102(2):403-406.
Ring, Alexander; Nguyen-Sträuli, Bich Doan; Wicki, Andreas; Aceto, Nicola (2023). Biology, vulnerabilities and clinical applications of circulating tumour cells. Nature Reviews Cancer, 23(2):95-111.
Lucaroni, Laura; Georgiev, Tony; Prodi, Eleonora; Puglioli, Sara; Pellegrino, Christian; Favalli, Nicholas; Prati, Luca; Manz, Markus G; Cazzamalli, Samuele; Neri, Dario; Oehler, Sebastian; Bassi, Gabriele (2023). Cross-reactivity to glutamate carboxypeptidase III causes undesired salivary gland and kidney uptake of PS-
MA-targeted small-molecule radionuclide therapeutics. European Journal of Nuclear Medicine and Molecular Imaging, 50(3):957-961. Grob, Tim; Sanders, Mathijs A; Vonk, Christian M; Kavelaars, Fran ҫ ois G; Rijken, Melissa; Hanekamp, Diana W; Gradowska, Patrycja L; Cloos, Jacqueline; Fløisand, Yngvar; van Marwijk Kooy, Marinus; Manz, Markus G; Ossenkoppele, Gert J; Tick, Lidwine W; Havelange, Violaine; Löwenberg, Bob; Jongen-Lavrencic, Mojca; Valk, Peter J M (2023). Prognostic Value of FLT3-Internal Tandem Duplication Residual Disease in Acute Myeloid Leukemia. Journal of Clinical Oncology, 41(4):756-765.
Adenaeuer, Anke; Barco, Stefano; Trinchero, Alice; Krutmann, Sarah; Nazir, Hanan Fawzy; Ambaglio, Chiara; Rocco, Vincenzo; Pancione, Ylenia; Tomao, Luigi; Ruiz-Sáez, Arlette; Echenagucia, Marion; Alesci, Sonja; Sollfrank, Stefanie; Ezigbo, Eyiuche D; Häuser, Friederike; Lackner, Karl J; Lämmle, Bernhard; Rossmann, Heidi (2023). Severe high-molecular-weight kininogen deficiency: clinical characteristics, deficiency–causing KNG1 variants, and estimated prevalence. Journal of Thrombosis and Haemostasis, 21(2):237-254.
Mansouri, Larry; Thorvaldsdottir, Birna; Sutton, Lesley-Ann; Karakatsoulis, Georgios; Meggendorfer, Manja; Parker, Helen; Nadeu, Ferran; Brieghel, Christian; Laidou, Stamatia; Moia, Riccardo; Rossi, Davide; Catherwood, Mark; Kotaskova, Jana; Delgado, Julio; Rodríguez-Vicente, Ana E; Benito, Rocío; Rigolin, Gian Matteo; Bonfiglio, Silvia; Scarfo, Lydia; Mattsson, Mattias; Davis, Zadie; Gogia, Ajay; Rani, Lata; Baliakas, Panagiotis; Foroughi-Asl, Hassan; Jylhä, Cecilia; Skaftason, Aron; Rapado, Inmaculada; Miras, Fatima; Martinez-Lopez, Joaquín; Zenz, Thorsten; et al (2023). Different prognostic impact of recurrent gene mutations in chronic lymphocytic leukemia depending on IGHV gene somatic hypermutation status: a study by ERIC in HARMONY. Leukemia, 37(2):339-347.
Ritter, Alexander; Meier, Julia; Angst, Florian; Rösler, Wiebke; Seeger, Harald (2023). Erdheim-Chester disease: hairy kidney and coated aorta. Kidney International, 103(2):431.
Sava, Mihaela; Bättig, Veronika; Gerull, Sabine; Passweg, Jakob R; Khanna, Nina; Garzoni, Christian; Gerber, Bernhard; Mueller, Nicolas J; Schanz, Urs; Berger, Christoph; Chalandon, Yves; van Delden, Christian; Neofytos, Dionysios; Stampf, Susanne; Franzeck, Fabian C; Weisser, Maja (2023). Bloodstream infections in allogeneic haematopoietic cell recipients from the Swiss Transplant Cohort Study: trends of causative pathogens and resistance rates. Bone Marrow Transplantation, 58(1):115-118.
Koch, Christian; Fleischer, Juliane; Popov, Todor; Frontzek, Karl; Schreiner, Bettina; Roth, Patrick; Manz, Markus G; Unseld, Simone; Müller, Antonia M S; Russkamp, Norman F (2023). Diabetes insipidus and Guillain-Barré-like syndrome following CAR-T cell therapy: a case report. Journal for ImmunoTherapy of Cancer, 11:e006059.
Dertschnig, Simone; Gergely, Peter; Finke, Jürgen; Schanz, Urs; Holler, Ernst; Holtick, Udo; Socié, Gérard; Medinger, Michael; Passweg, Jakob; Teshima, Takanori; Stylianou, Christos; Oehen, Stephan; Heim, Dominik; Bucher, Christoph (2023). Mocravimod, a Selective Sphingosine-1-Phosphate Receptor Modulator, in Allogeneic Hematopoietic Stem Cell Transplantation for Malignancy. Transplantation and Cellular Therapy, 29(1):41.e1-41.e9.
Benoit, Tobias Matthieu; Gundermann, Stefan (2023). 53-jähriger Patient mit unklarer Anämie und Hyperkalzämie. Deutsche Medizinische Wochenschrift, 148(1-02):15-16.
Nilius, Henning; Cuker, Adam; Haug, Sigve; Nakas, Christos; Studt, Jan-Dirk; Tsakiris, Dimitrios A; Greinacher, Andreas; Mendez, Adriana; Schmidt, Adrian; Wuillemin, Walter A; Gerber, Bernhard; Kremer Hovinga, Johanna A; Vishnu, Prakash; Graf, Lukas; Kashev,
68
Alexander; Sznitman, Raphael; Bakchoul, Tamam; Nagler, Michael (2023). A machine-learning model for reducing misdiagnosis in heparin-induced thrombocytopenia: A prospective, multicenter, observational study. eClinicalMedicine, 55:101745.
Christ, Sebastian M; Heesen, Philip; Muehlematter, Urs J; Pohl, Kaspar; William Thiel, Gabriel; Willmann, Jonas; Ahmadsei, Maiwand; Kroese, Tiuri E; Mayinger, Michael; Balermpas, Panagiotis; Wicki, Andreas; Andratschke, Nicolaus; Huellner, Martin; Guckenberger, Matthias (2023). Recognition of and treatment recommendations for oligometastatic disease in multidisciplinary tumor boards. Clinical and Translational Radiation Oncology, 38:123-129.
Rovó, Alicia; Gavillet, Mathilde; Drexler, Beatrice; Keller, Peter; Schneider, Jenny Sarah; Colucci, Giuseppe; Beauverd, Yan; van Dorland, Hendrika Anette; Pollak, Matthias; Schmidt, Adrian; De Gottardi, Andrea; Bissig, Marina; Lehmann, Thomas; Duchosal, Michel A; Zeerleder, Sacha (2023). Swiss Survey on current practices and opinions on clinical constellations triggering the search for PNH clones. Frontiers in Medicine, 10:1200431.

69

14 MOH Retreat 2022, Karthause Ittingen 70
Team
www.usz.ch/fachbereich/medizinische-onkologie-und-haematologie/team

71
Universitätsspital Zürich
Klinik für Medizinische Onkologie und Hämatologie (MOH)
Rämistrasse 100
8091 Zürich
www.usz.ch/moh
Folgen Sie dem USZ unter
Wir wissen weiter.